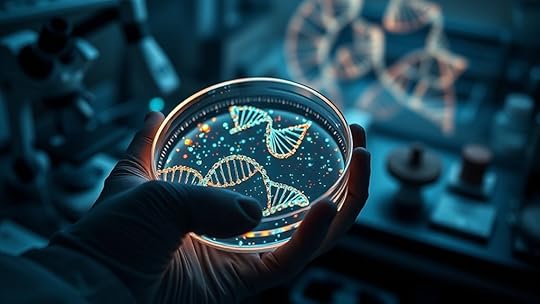

Michelle Nelson-Schmidt's Blog, page 34
July 26, 2025
Will Climate Change Create New Sea Monsters? Oceanographers Explain
Climate change is drastically altering marine habitats, pushing species to adapt, migrate, or face extinction. These rapid changes can lead to new evolutionary processes, possibly creating unique or even mythical-like creatures. As ocean currents shift and environments become more unstable, some new species might resemble stories of legendary sea monsters. If you want to explore how science explains these transformations and what the future holds for marine life, there’s more to discover.
Key TakeawaysClimate change may drive the evolution of new, uniquely adapted marine species, but not mythical monsters.Deep sea discoveries reveal bioluminescent and ancient species, hinting at potential new marine life forms.Habitat alterations and environmental pressures can lead to rapid evolution and divergence of species.Changes in ocean conditions might foster the emergence of novel species with unusual traits.Myths of sea monsters lack scientific basis; climate change is unlikely to create legendary creatures.How Climate Change Is Altering Marine Habitats
As climate change accelerates, it directly impacts marine habitats in ways you can’t ignore. Coral bleaching occurs when rising sea temperatures stress corals, causing them to expel the algae that give them color and nutrients. Without these algae, corals turn white and become vulnerable to disease. At the same time, ocean acidification—caused by increased carbon dioxide absorption—weakens coral skeletons and other marine structures. This makes habitats less stable and less hospitable for countless species. These changes threaten the biodiversity of our oceans and disrupt the delicate balance of marine ecosystems. You may not see these effects directly, but they ripple through the entire food chain, affecting fisheries, coastal communities, and the health of the planet as a whole.
The Impact of Rising Temperatures on Marine Species
Rising ocean temperatures have a profound effect on marine species, forcing many to adapt, migrate, or face extinction. Deep sea megafauna, once stable in cold depths, now encounter shifting habitats and food sources. Marine adaptation becomes crucial as species seek cooler waters or alter their behaviors. You might imagine a large squid or whale navigating unfamiliar territories, struggling to survive. The table below illustrates these changes:
Species TypeResponse to Temperature RiseDeep Sea MegafaunaMigration to cooler depths or declineCoral ReefsBleaching and loss of habitatSmall FishAltered breeding cyclesThese adaptations highlight the resilience—and vulnerability—of marine life as temperatures climb.
Shifting Ocean Currents and Their Role in Species Distribution
Shifting ocean currents play a significant role in altering the distribution of marine life in a warming world. As currents change, species must adapt their migratory patterns, sometimes moving toward new habitats. This can impact deep sea vents, which rely on stable conditions, causing organisms to relocate or face decline. Changes in currents also influence nutrient flow, affecting food availability across different regions. Here are three key effects:
Migratory patterns shift, leading to new species interactions.Deep sea vent communities mayface displacement or extinction.Nutrient distribution becomes uneven, impacting growth zones.Potential for New Species to Evolve in Changing Environments
As climate change creates new habitats, you’ll see species face fresh evolutionary pressures. These changes can lead to increased genetic diversity as organisms adapt to harsh or shifting environments. This process might give rise to entirely new species better suited for the evolving ocean landscape.
New Habitats FormationChanging climates are creating new habitats that can serve as breeding grounds for emerging species. As ocean temperatures rise, coral bleaching transforms vibrant reefs into barren landscapes, forcing marine life to seek new environments. Simultaneously, deep sea vents become more essential, providing stable, heat-rich zones where life can thrive despite surface changes. These shifts open opportunities for species to adapt or evolve in previously uninhabitable areas.
Here are three ways these habitats influence new species:
Coral bleaching forces species to migrate or adapt to survive.Deep sea vents offer refuge for organisms resistant to extreme conditions.New habitats increase genetic diversity, fostering evolution in isolated environments.Evolutionary Pressure ShiftsWhen environmental conditions transform rapidly, species face new selective pressures that can accelerate evolutionary processes. You might see organisms develop novel adaptation mechanisms to survive in changing habitats, such as altered temperature tolerances or shifted feeding strategies. These pressures influence evolutionary pathways, guiding species toward new traits that better suit the evolving environment. As ocean conditions shift due to climate change, some species may follow accelerated adaptation mechanisms, leading to rapid evolution. This process can produce entirely new traits or even new species over relatively short timeframes. In these dynamic settings, natural selection favors individuals best equipped to handle stressors like warmer waters or acidification, increasing the likelihood of unique evolutionary outcomes. You’re witnessing evolution in action, driven by the urgent need to adapt to a rapidly changing ocean.
Genetic Diversity ExpansionHave you ever wondered how environmental upheavals can lead to the emergence of entirely new species? Climate change can boost genetic diversity within populations, giving species more options for adaptation. This increased genetic variation helps organisms survive in unpredictable environments. When conditions shift rapidly, species with broader genetic diversity can develop new traits more quickly, fueling evolution. Here’s how it works:
Genetic diversity provides a broader pool of traits for natural selection to act upon.Species adaptation accelerates as populations respond to changing conditions.New species may emerge when distinct genetic groups diverge over time.Myth vs. Reality: Are New Sea Monsters Plausible?
Is it possible that new sea monsters still lurk deep beneath the waves? Many believe that deep sea mysteries hide creatures we’ve only dreamed of, fueling myths of mythical creatures. However, modern science suggests otherwise. While the ocean’s depths are vast and largely unexplored, the idea of entirely new, monstrous beings emerging due to climate change isn’t highly plausible. Most sightings of supposed sea monsters are misidentifications of known marine animals or natural phenomena. The deep sea is extreme, but it’s not a breeding ground for mythical creatures or monsters in the traditional sense. Instead, it’s a frontier for scientific discovery, revealing strange but real animals adapted to extreme conditions. So, the myth of new sea monsters remains largely a mesmerizing story rather than a scientific reality.
Scientific Discoveries: Uncovering Unknown Marine Creatures
Scientific discoveries continue to surprise us with the discovery of previously unknown marine creatures, revealing how much remains hidden beneath the ocean’s surface. Recent advances have uncovered astonishing examples like deep sea bioluminescent animals that glow in the darkness, providing insights into survival strategies in extreme environments. Additionally, marine fossil discoveries reveal ancient species, helping us understand evolutionary changes over millions of years. Here are some exciting developments:
Bioluminescent creatures, such as anglerfish and jellyfish, illuminate deep-sea habitats, showcasing nature’s adaptation to darkness.Marine fossil discoveries reveal extinct species, offering clues about past ocean ecosystems and how they might react to current climate changes.Researchers continue to explore uncharted depths, hinting at the possibility of discovering completely new species that could resemble mythical sea monsters.What the Future Holds for Marine BiodiversityDeep-sea bioluminescent animals and ancient fossils reveal secrets of Earth’s hidden marine world.

As climate change accelerates, the future of marine biodiversity hangs in the balance, with shifting temperatures and acidification threatening countless species. You’ll see changes in deep sea bioluminescence patterns as some organisms struggle to adapt, altering the mysterious glow that sustains deep ecosystems. Marine mammal migration routes will shift or become more unpredictable as warming waters disrupt traditional breeding and feeding grounds. Some species may decline or disappear, while others could emerge in new regions, creating unpredictable ecosystems. These changes could lead to a loss of biodiversity and disrupt oceanic food chains. You might witness the ocean’s vibrant life transforming rapidly, with some species thriving and others fading away, fundamentally reshaping the marine world you once knew.
Frequently Asked QuestionsCould Climate Change Lead to Entirely New Marine Ecosystems?Climate change could profoundly alter marine biodiversity and oceanic habitats, leading to the emergence of entirely new ecosystems. As temperatures rise and acidity increases, some species may adapt or migrate, while others may vanish. You might see shifts in predator-prey relationships and the formation of novel habitats, affecting the overall balance. These changes could create unforeseen marine environments, highlighting the need to understand and protect our oceanic ecosystems for future stability.
How Quickly Might New Species Adapt to Changing Ocean Conditions?The ball’s in your court when it comes to how quickly species can adapt to changing ocean conditions. Genetic adaptation varies, and evolutionary timescales can be slow or rapid depending on the species’ reproductive rates and genetic diversity. Some organisms might keep pace with climate change, while others lag behind. You should understand that adaptation is a complex process influenced by multiple factors, making precise predictions tricky but vital for future ecosystems.
Are There Historical Precedents for Rapid Marine Species Evolution?You wonder if rapid marine species evolution has occurred before. Historically, deep-sea environments have seen evolutionary leaps during abrupt changes, like mass extinctions. These events forced species to adapt quickly, leading to new forms and behaviors. Such precedents suggest that, as ocean conditions shift rapidly today, we might see similar evolutionary leaps, giving rise to entirely new marine species capable of thriving in changing deep-sea ecosystems.
What Role Do Deep-Sea Environments Play in Potential New Species Formation?The deep sea is like a hidden universe teeming with potential, shaping new species through deep sea speciation. You might not realize it, but these environments hold countless unique environmental niches, fostering evolution in isolation. As conditions shift, these niches could spark rapid adaptations, making the deep sea a powerhouse for future biodiversity. So, it’s essential to understand how these dark depths influence the evolution of life on Earth.
Can Climate Change Cause Existing Marine Predators to Become More Aggressive?Climate change can definitely cause marine predators to become more aggressive. You might notice marine behavioral changes, like increased hunting activity or territoriality, as predators adapt to shifting conditions. These changes can disrupt predator-prey dynamics, leading to more intense encounters and competition. As ocean temperatures rise and food sources become scarce, marine predators may become bolder, affecting the entire ecosystem balance you depend on and highlighting the urgency of addressing climate impacts.
ConclusionAs you see, climate change is reshaping our oceans and could lead to surprises beneath the waves. While the idea of new sea monsters makes for great stories, science shows that evolution and adaptation are more subtle but equally fascinating. Keep in mind, the ocean’s depths hold many secrets, and as the saying goes, “still waters run deep.” Stay curious, because the more we learn, the more incredible our underwater world becomes.
July 24, 2025
Future Cryptid Tourism: Predicting Hotspots of 2125
By 2125, future cryptid tourism will thrive with virtual reality tours of Loch Ness and underwater explorations of legends like the Kraken. Natural hotspots such as hidden valleys for chupacabras, enchanted forests for Mothman, and remote mountain ranges for Yeti sightings will attract explorers. Subterranean caves and urban legends will also draw crowds. Discover more about how technology and legends will shape these exciting adventure zones as you continue.
Key TakeawaysMountain, subterranean, and urban sites will remain top cryptid tourism hotspots in 2125 due to rich folklore and exploration opportunities.Advanced VR, underwater, and sensor technologies will enable immersive and safer cryptid expeditions, attracting more enthusiasts.Natural environments like enchanted forests, hidden valleys, and mountain ranges will host guided tours and specialized expeditions.Subterranean caves and urban landmarks will become popular for underground and city-based cryptid explorations and storytelling.Mythology and local legends will continue to drive interest, with evolving tech enhancing the authenticity and thrill of future cryptid tourism.Virtual Reality Expeditions to the Loch Ness
Although physical visits to Loch Ness remain popular, virtual reality expeditions now offer an immersive alternative that puts you right on the water’s surface. With cutting-edge VR technology, you can explore the legendary depths where the mythical aquatic creature is said to dwell. As you glide through shimmering waters, you’ll encounter scenes inspired by forest folklore, where ancient trees and hidden creatures intertwine with the legend of Nessie. These virtual journeys allow you to experience the mystique of the loch without leaving your home, bringing to life stories passed down through generations. Whether you’re a skeptic or a believer, this technology offers a mesmerizing glimpse into the enchanted world that surrounds one of Scotland’s most enduring legends.
Deep-Sea Encounters With the Kraken of Legends
As you explore hidden oceanic domains, advanced underwater exploration tech reveals mysterious depths where legendary creatures like the Kraken might lurk. Sightings of these colossal beings continue to fuel curiosity and debate among explorers and scientists alike. With groundbreaking technology, you can now witness these elusive giants firsthand, challenging what we thought was possible beneath the waves.
Hidden Oceanic RealmsBeneath the ocean’s surface lies a mysterious world where legends like the Kraken still capture imaginations. In these hidden oceanic realms, you’ll explore bioluminescent ecosystems that glow with alien beauty. The abyssal mystery zones, extreme depths cloaked in darkness, harbor secrets waiting to be uncovered. To navigate this domain, you should understand:
The unique adaptations of creatures thriving in darkness.How bioluminescence aids in communication and hunting.The geological features shaping these abyssal zones.The ongoing discovery of new cryptids and legendary beings.These depths challenge explorers with their inaccessibility and awe-inspiring complexity, making them prime hotspots for future cryptid tourism and legends yet to be written.
Legendary Creature SightingsDeep-sea explorers have reported startling sightings of massive, tentacled creatures that resemble the legendary Kraken, fueling speculation about their existence. These encounters are often considered part of cryptid folklore, blending myth with mystery. Many eyewitnesses describe enormous, shadowy forms emerging from the depths, their size and power surpassing known marine life. These legendary sightings attract thrill-seekers and cryptid enthusiasts keen to witness the creature firsthand. As technology advances, more credible reports emerge, slowly shifting the perception of this deep-sea behemoth from myth to potential reality. The allure of discovering such a legendary creature continues to inspire curiosity, making these sightings a focal point for future cryptid tourism hotspots. Your journey into the depths could reveal secrets long buried in oceanic legend.
Underwater Exploration TechAdvances in underwater exploration technology are transforming the way we seek out legendary creatures like the Kraken. Modern tools like underwater drone technology allow you to explore deep-sea environments where bioluminescent plankton illuminate the darkness, creating natural signals of activity. These drones can:
Capture high-resolution images of deep-sea habitatsDetect bioluminescent signals indicating creature presenceNavigate complex terrains with autonomyCollect samples for scientific analysisWith these innovations, you can venture into regions once thought unreachable, increasing the chances of encountering mythical beings. Enhanced sensors and real-time data streaming enable precise tracking of legendary cryptids. As technology advances, your chances of underwater encounters with the Kraken of legends become more attainable, opening a new era of cryptid tourism.
Exploring the Hidden Valleys for Chupacabra Sightings
As you explore the hidden valleys, dense vegetation creates perfect cover for elusive chupacabras. At night, strange animal calls echo through the darkness, heightening your senses. Local legends offer stories of firsthand encounters, fueling your curiosity to uncover the truth.
Valleys With Dense VegetationDense vegetation blankets many hidden valleys, making them prime spots for elusive chupacabra sightings. These valleys are concealed by dense foliage and hidden groves that obscure visibility and create perfect cover. When exploring these areas, consider:
The density of plant life, which provides natural camouflage.The presence of narrow trails that lead into secluded spots.The variety of flora supporting potential prey for chupacabras.The proximity to water sources, attracting and sustaining cryptid activity.Navigating these valleys requires patience and keen observation. The thick canopy and tangled undergrowth challenge even seasoned explorers, but they also increase the chances of a rare encounter. If you’re seeking chupacabras, these dense valleys could hold the secrets you’re after.
Nighttime Animal CallsWhen exploring the hidden valleys at night, listening to animal calls becomes one of your best tools for detecting elusive chupacabras. The nocturnal soundscapes are rich with clues, each call hinting at what’s nearby. By honing your animal call identification skills, you can distinguish between common wildlife and potential cryptid signals. Chupacabras are believed to produce distinctive sounds, often unlike typical predators or prey. Pay attention to high-pitched, irregular howls or faint shuffles in the foliage. These sounds may blend into the natural symphony but can stand out to experienced ears. Using specialized audio equipment, you can record and analyze these calls later, increasing your chances of confirming a sighting. Mastering nocturnal soundscapes transforms silent woods into a treasure trove of cryptid clues.
Local Legend EncountersLocal legends about chupacabras have persisted in the hidden valleys for generations, fueling curiosity and caution among explorers. These local legend encounters often involve mysterious sightings, night-time sounds, and fleeting shadows. To deepen folklore preservation, consider these key aspects:
Document sightings meticulously to support local legend encounters.Engage with indigenous communities to understand oral histories.Use advanced tracking technology while respecting the environment.Participate in local folklore preservation efforts to maintain cultural integrity.The Enchanted Forests of the Mothman Mysteries
The Enchanted Forests of the Mothman Mysteries have become a popular destination for cryptid enthusiasts seeking both adventure and answers. Visitors arrive excited to witness mothman sightings firsthand and immerse themselves in enchanted forest exploration. As you navigate the dense, mist-shrouded woods, you may catch glimpses of glowing eyes or hear distant, haunting wings fluttering. The forests’ mysterious atmosphere fuels stories of strange lights and unexplained phenomena, drawing thrill-seekers and researchers alike. Guided tours utilize advanced technology to track cryptid activity while respecting the environment. This fusion of nature and mystery makes the enchanted forests a hotspot for those determined to uncover the truth behind the legendary mothman and experience the magic of these surreal woods firsthand.
Remote Mountain Ranges and the Yeti Frontier
Venture into the remote mountain ranges of the Yeti Frontier, where rugged terrain and extreme weather keep these mysterious peaks hidden from most eyes. Here, ancient mountain myths echo through the icy ridges, fueling cryptid intrigue. You’ll explore remote yeti habitats that have remained untouched for centuries. To maximize your experience, consider:
Wayfinding treacherous passes with expert guidesSpotting signs of elusive yeti activityVisiting local villages with folklore tied to these legendsUsing advanced sensors designed for extreme environmentsThese mountains preserve a mystique that attracts dedicated cryptid explorers. As you venture deeper, you’ll uncover the secrets of these ancient myths, fueling speculation about what truly lurks among the peaks. This frontier promises an unparalleled blend of adventure and legend.
Subterranean Adventures for the Mongolian Death Worm
Beneath Mongolia’s vast, arid steppes lies a labyrinth of underground tunnels and caves where the legendary Mongolian Death Worm is said to dwell. These mystery tunnels branch into complex subterranean habitats, offering a thrilling adventure for daring explorers. You’ll navigate dark, twisting passages, searching for signs of the elusive creature while avoiding natural hazards. Guides equipped with advanced mapping tech lead you through the hidden underground world, revealing secrets that have remained untouched for centuries. The subterranean habitats are believed to be integral to the worm’s survival, making each exploration a race to uncover clues before it vanishes into the depths again. If you crave a mix of mystery and adrenaline, these subterranean adventures promise an unforgettable encounter with one of cryptid folklore’s most enigmatic beings.
Urban Cryptid Tours: City Legends Come Alive
As city streets bustle with activity, legends of cryptids lurking in urban shadows come to life through guided tours that immerse you in local folklore. These urban cryptid tours reveal the hidden stories behind city legends, blending myth with reality. You’ll explore sites connected to legendary creatures, uncovering the truth behind mysterious sightings. The experience includes:
Visiting historic landmarks tied to urban legendsListening to tales from local storytellersObserving cryptid-inspired art installationsParticipating in interactive folklore reenactmentsThese tours make city folklore tangible, allowing you to walk through the mythic side of urban life. As cryptid legends evolve with each generation, city-based adventures keep the mysteries alive, engaging both locals and tourists alike.
Frequently Asked QuestionsHow Will Future Technology Enhance Cryptid Tourism Experiences?Future technology will considerably enhance your cryptid tourism experiences. You’ll use augmented reality to see mythical creatures in real-world settings, making encounters more vivid and immersive. Bioengineering techniques could create realistic, safe cryptid replicas for closer observation. These innovations let you explore legendary beings without risk, transforming how you interact with cryptids and making your adventures more engaging, educational, and unforgettable.
What Safety Measures Will Be Implemented During High-Risk Cryptid Encounters?Did you know that 78% of high-risk cryptid encounters could be prevented with proper safety measures? During these encounters, strict cryptid encounter protocols will be in place, ensuring your safety. You’ll also benefit from safety gear advancements, like adaptive suits and sensory shields, designed to protect you. These measures aim to keep thrill-seekers safe while exploring the mysterious, ensuring you experience excitement without unnecessary risk.
How Might Local Communities Benefit Economically From Cryptid Tourism?You’ll see local communities benefiting economically from cryptid tourism through increased local economic growth and community engagement. As visitors seek out these mysterious creatures, your community can host guided tours, festivals, and accommodations that boost revenue. This tourism encourages local businesses and fosters pride and collaboration among residents. Overall, cryptid tourism can transform your area into a lively, thriving destination, creating lasting economic and social benefits.
Will There Be Regulations Protecting Cryptids During Tourism Activities?Think of cryptids as delicate butterflies in a bustling garden. You’ll likely see tourism regulations designed to protect these mysterious creatures, ensuring they’re not harmed by curious visitors. Cryptid protection becomes a priority, with rules that balance tourism and conservation. By implementing these regulations, communities can preserve the allure of cryptids while allowing safe, respectful exploration, keeping the magic alive for generations to come.
How Will Cryptid Tourism Adapt to Environmental Changes Over Time?You’ll see cryptid tourism adapt as ecological shifts and habitat migration reshape landscapes. To keep up, tour operators will modify routes, focus on regions experiencing environmental change, and develop new ways to observe cryptids responsibly. You might also encounter advanced tracking technology and eco-friendly practices, ensuring tourism supports cryptid habitats rather than damaging them. This proactive approach helps preserve cryptids’ environments amid ongoing ecological shifts.
ConclusionAs you step into the future of cryptid tourism, you become an explorer charting uncharted worlds like a brave captain steering through mysterious seas. Each expedition is a key to open hidden stories, turning legends into living adventures. Embrace this journey as if you’re opening a secret door to wonder—a domain where myths breathe and history whispers. Get ready to chase shadows and find your own legendary tale, just waiting to be discovered.
July 23, 2025
Terraforming Venus for Vampires: A Thought Experiment
Transforming Venus into a haven for vampires involves multiple steps. You’d start by creating a darkness-promoting atmosphere with reflective particles to block sunlight and maintain long-term shadows. Next, you’d modify surface temperatures with solar collectors or reflective materials, and develop pressure-resistant habitats with biological adaptations for extreme conditions. Sustainable energy sources like solar or geothermal power would support your colony, while addressing ecological risks and ethical considerations. Want to learn how all these elements come together? Keep exploring.
Key TakeawaysModifying Venus’s surface temperature and atmosphere to create a stable, dark environment suitable for vampire adaptation.Introducing atmospheric aerosols and reflective particles to block sunlight and maintain perpetual darkness.Developing biological traits in vampires for extreme resilience against high temperatures, toxic gases, and radiation.Constructing pressure-resistant habitats with advanced shielding to sustain life amid Venus’s extreme surface conditions.Addressing ethical and ecological considerations to prevent planetary destabilization and preserve potential intrinsic planetary value.Assessing Venus’s Original Environment and Challenges
Venus’s original environment posed significant obstacles to any form of life or colonization. Its intense volcanic activity constantly reshapes the planet’s surface, releasing gases and creating a hostile landscape. Historically, Venus’s atmosphere composition was thick with carbon dioxide, with clouds of sulfuric acid that made the surface nearly impossible to access. The planet’s surface temperature soared due to a runaway greenhouse effect, trapping heat relentlessly. These conditions resulted in a crushing pressure at the surface—over 90 times that of Earth’s—making it an extreme environment. Understanding Venus’s volcanic activity and its historical atmosphere composition reveals why early colonization efforts failed and highlights the immense challenges in transforming this hostile world into a livable space.
Designing a Darkness-Promoting Atmosphere
To create an atmosphere that promotes darkness, you need to maximize shadow coverage and absorb as much solar radiation as possible. This involves selecting materials and structures that block or reflect light efficiently. By controlling light levels, you can guarantee the nighttime environment stays suitably shadowy for vampire habitats.
Maximizing Shadow CoverageHave you considered how atmospheric composition can be manipulated to maximize shadow coverage on Venus? By increasing aerosols or reflective particles, you can create a denser, darker atmosphere that blocks sunlight more effectively. This sustained darkness benefits bat habitats and nocturnal ecosystems, encouraging creatures that thrive in shadows. To achieve this, you might:
Introduce thick, dark aerosols that scatter sunlight away from the surfaceUse reflective atmospheric layers to bounce light back into spaceAdjust atmospheric gases to sustain a perpetual twilight, deepening shadowsThese modifications assure extended periods of darkness, supporting vampire-friendly environments and nocturnal biodiversity. Such an atmosphere not only fosters shadow coverage but also stabilizes the conditions needed for a thriving, shadow-dependent biosphere.
Absorbing Solar RadiationBuilding on the idea of maximizing shadow coverage, manipulating atmospheric properties to absorb solar radiation can deepen darkness even further. You can achieve this through advanced radiation management techniques that enhance solar absorption. By introducing dark, high-albedo particles or aerosols into the atmosphere, you increase the atmosphere’s capacity to soak up sunlight before it reaches the surface. Reflective surfaces are minimized, while absorbing particles are optimized for maximum solar energy capture. This process reduces surface illumination, creating a perpetual dim environment suited for vampires. Precise control of atmospheric composition allows you to limit incoming radiation efficiently, ensuring minimal light penetrates, and maintaining the darkness necessary for your nocturnal inhabitants. Effective radiation management becomes essential in creating an environment of sustained, unrelenting darkness.
Enhancing Nighttime DarknessCreating an atmosphere that promotes maximum darkness requires actively manipulating atmospheric components to block out residual light. You’ll aim to reduce atmospheric scattering and reflectivity, ensuring the night sky remains pitch black. This fosters moonlit biomes, where nocturnal adaptations thrive in the absence of bright light. To achieve this, you might introduce dense aerosols that absorb or deflect stray photons or deploy reflective shields to minimize atmospheric glare. Consider the following:
Thick, light-absorbing aerosols to minimize residual glowReflective layers to redirect stray light away from the surfaceCloud formations designed to trap and prevent light escapeThese measures create an environment where vampires and nocturnal creatures flourish, thriving in an unrelenting darkness that enhances their natural adaptations.
Modifying Surface Conditions for Extreme Temperatures
To create an environment suitable for vampires, you’ll need to achieve extreme heat on Venus’s surface. Managing this intense temperature requires controlling the surface atmosphere and its interactions with solar radiation. How you handle these factors will determine whether the planet becomes a suitable domain for your dark ambitions.
Achieving Extreme HeatAchieving extreme heat on Venus requires a deliberate manipulation of its surface and atmospheric conditions to trap more solar energy. You can do this by enhancing solar absorption and reducing heat loss. Deploying large-scale solar collectors will maximize energy intake, while reflective surface materials can trap heat efficiently. To prevent solar wind from stripping away essential atmospheric gases, you’d install powerful magnetic shielding, mimicking a magnetic field. This shield directs solar wind particles away, preserving the atmosphere’s density and heat-retention capacity. Visualize a planet with a thick, heat-absorbing crust and an atmosphere thick with greenhouse gases, continuously amplifying surface temperatures. The magnetic shield acts as a barrier, ensuring the planet’s surface remains exposed to maximum solar radiation, driving up temperatures to extreme levels suitable for vampires.
Managing Surface AtmosphereManipulating surface conditions directly influences Venus’s ability to sustain extreme heat. By adjusting atmospheric composition, you can control surface temperatures essential for vampire survival. Introducing alien flora that absorbs heat or reflects sunlight can help moderate temperatures. Celestial mechanics, like shifting Venus’s rotation or orbit, could also influence heat distribution. To visualize options:
MethodEffectReflective aerosolsReduce surface heat via sunlight reflectionAlien floraAbsorbs or redirects heat, stabilizing tempsOrbital adjustmentsChange insolation patterns, cooling surfaceAtmospheric gasesTrap or release heat, managing extremesYour goal is to balance extreme heat, ensuring the surface remains habitable for your vampire ecosystem while preventing runaway temperature rises.
Developing Pressure-Resistant Structures and Ecosystems
Since Venus’s extreme atmospheric pressure and corrosive environment pose significant challenges, developing pressure-resistant structures and ecosystems becomes essential for any terraforming effort. You must create habitats that withstand crushing pressures and prevent atmospheric degradation. These structures need advanced materials to ensure durability and safety. Climate stabilization depends on maintaining the right atmospheric composition inside habitats, shielding inhabitants from Venus’s harsh exterior. To achieve this, you’ll incorporate cooling systems and corrosion-resistant alloys. Consider these key elements:
Reinforced, multi-layered domes with pressure-equalizing ventsSubsurface ecosystems insulated from surface conditionsAutomated systems for atmospheric regulation and corrosion controlDevelop pressure-resistant habitats with advanced materials, cooling, and corrosion-resistant alloys to survive Venus’s extreme environment.
Designing resilient ecosystems will help sustain life, supporting the goal of stabilizing the climate and maintaining safe atmospheric conditions for vampires. Your focus remains on creating sustainable, pressure-equalizing environments amid the planet’s extreme environment.
Introducing Biological Adaptations for Vampire Survival
To guarantee vampires can survive on Venus, biological adaptations must complement the engineered habitats. You’ll focus on enhancing biological resilience, enabling your vampire population to withstand extreme conditions like high temperatures and toxic atmospheres. Evolutionary adaptations will be essential; over generations, vampires could develop traits such as radiation tolerance, UV resistance, and metabolic shifts to optimize energy intake in the Venusian environment. These adaptations could include specialized skin that reflects heat or filters harmful rays, and internal systems that conserve water and nutrients. By fostering these biological traits, you assure vampires become self-sustaining entities capable of thriving beyond initial technological support. This integration of biology and engineering creates a robust survival strategy tailored specifically to Venus’s hostile environment.
Engineering Sustainable Energy and Resource Systems
Creating sustainable energy and resource systems on Venus requires innovative engineering solutions that can operate efficiently in the planet’s extreme environment. You must harness Venus’s unique features, like its magnetic field, to protect infrastructure from intense solar radiation. Adjusting the atmospheric composition becomes essential to support energy generation and resource extraction. You might develop magnetically shielded energy stations that utilize solar or geothermal power. Additionally, atmospheric manipulation could enhance resource availability or reduce harmful gases.
Deploy magnetically shielded solar arrays to capture sunlight effectively.Use atmospheric processing to extract critical gases and stabilize the environment.Integrate magnetic field generators to safeguard energy infrastructure from radiation.Addressing Potential Biological and Ecological RisksInnovative engineering on Venus harnesses magnetic fields and atmospheric manipulation to enable sustainable energy and resource systems.

Addressing potential biological and ecological risks on Venus is crucial to prevent unintended consequences from terraforming efforts. You must consider biological risks, such as introducing Earth organisms that could become invasive or disrupt existing planetary conditions. Ecological concerns also arise if altered environments favor certain species over others, leading to loss of native-like systems. Since Venus’s atmosphere and surface are vastly different from Earth, even minimal biological contamination could trigger unpredictable reactions. You’ll need strict containment protocols and thorough risk assessments to avoid creating harmful ecosystems or jeopardizing future colonization. Recognizing these risks ensures that terraforming processes remain controlled, minimizing damage to the planet’s evolving environment. Careful planning and monitoring help prevent ecological destabilization and safeguard against irreversible biological impacts.
Implications for Planetary Engineering and Ethical Considerations
When undertaking planetary engineering on Venus, you must carefully weigh the ethical implications of altering an entire world. Planetary ethics challenge you to deliberate whether such transformation respects the intrinsic value of the planet’s existing state. You also need to evaluate the ecological impact, including potential harm to unknown or undiscovered life forms. Altering Venus raises questions about humanity’s responsibility and the potential consequences for future generations.
How do you balance progress with respect for natural planetary systems?What obligations do you have to preserve or protect the planet’s integrity?Is it ethical to modify a planet solely for specific species, like vampires, at the expense of broader ecological stability?These considerations guide responsible decision-making in planetary engineering, emphasizing the importance of ethics alongside technological ambition.
Future Possibilities: Beyond Vampires in Space
Looking beyond the immediate goal of transforming Venus for vampire habitation opens up a domain of possibilities for humanity’s future in space. You could explore advanced space colonization, establishing thriving communities on moons or planets, and even seek signs of extraterrestrial life. This effort might *unlock* insights into biology, evolution, and the universe’s origins. Imagine creating self-sustaining habitats that support diverse life forms, fostering interstellar ecosystems. The table below illustrates potential future ventures:
Mission TypeGoalLunar ColonizationPermanent settlements on the MoonMars HabitatsRed planet research stations and coloniesAsteroid MiningExtracting resources for space expansionExobiology ResearchStudying extraterrestrial life formsInterstellar TravelReaching distant star systemsThese endeavors could redefine humanity’s place in the cosmos.
Frequently Asked QuestionsCould Vampire Biology Evolve Naturally in Venus’S Environment?You wonder if vampire biology could evolve naturally on Venus. Given Venus’s extreme heat, crushing pressure, and toxic atmosphere, vampire metabolism would need significant Venusian adaptations. Over millions of years, you might see creatures developing thick skins, efficient oxygen processing, and heat-resistant features. These Venusian adaptations could support a vampire-like metabolism, enabling survival in such harsh conditions, but it would require extraordinary evolutionary changes unlikely without human intervention.
How Would Vampire Social Structures Adapt to an Alien Ecosystem?You’d see vampire social structures shift dramatically in an alien ecosystem. The vampire hierarchy might become more fluid, adapting to new challenges and resources like the Blood economy, which could depend on alien flora or fauna. As survival becomes key, social roles may blur, with some vampires taking on leadership based on knowledge of the environment rather than traditional dominance. This evolution would redefine how vampires organize and sustain their society.
What Legal Frameworks Govern Extraterrestrial Biological Modifications?Imagine extraterrestrial patent laws are like the rules of a cosmic game you’re just learning. You’re governed by space biological rights that protect innovations beyond Earth, but these laws are still evolving. You must navigate international treaties and agreements that regulate biological modifications outside our planet. Staying compliant guarantees your work respects legal boundaries, helping you contribute responsibly to the future of space biotech and avoid legal pitfalls.
Are There Potential Unintended Ecological Consequences of Terraforming for Vampires?You should consider that terraforming for vampires could cause ecological imbalance, disrupting existing ecosystems. Unintended mutations might arise in native species, leading to unpredictable consequences. These changes could threaten biodiversity and destabilize the environment. You might inadvertently create new invasive organisms or alter climate patterns, making the planet less hospitable. It’s essential to assess these risks thoroughly to prevent long-term ecological damage.
Could Other Mythical Creatures Be Feasibly Integrated Into Venus’S Environment?You wonder if other mythical creatures could fit into Venus’s environment. It’s possible to imagine a mythical predator thriving alongside supernatural flora, creating a complex ecosystem. You’d need to contemplate how these beings interact with the environment and each other. While fantastical, integrating such creatures would require careful planning to balance the ecosystem, ensuring that these mythical predators and supernatural flora coexist without causing ecological chaos.
ConclusionAs you imagine transforming Venus into a vampire haven, remember that this dream is like chasing a moonbeam—beautiful but elusive. Though the challenges are formidable, your innovative spirit can push boundaries, shaping worlds beyond imagination. With each bold step, you breathe life into a vision that’s as dark and mysterious as the night itself. Keep dreaming, for in your hands, even the impossible becomes a shadow waiting to be cast.
July 22, 2025
Can Quantum Computing Finally Decode the Yeti DNA Mystery?
Quantum computing could finally help you crack the Yeti DNA mystery by analyzing tiny, ancient samples faster and more accurately than traditional methods. While challenges like sample contamination and technology limitations exist, recent advances suggest quantum tech might identify hidden genetic patterns and authenticate folklore. Although skepticism remains, ongoing developments promise new horizons for uncovering cryptid mysteries. If you’re curious about how science aims to turn myths into verified facts, there’s more to explore ahead.
Key TakeawaysQuantum computing can accelerate genetic analysis, potentially identifying Yeti DNA from degraded or contaminated samples.Its advanced algorithms may uncover hidden genetic patterns, aiding in verifying the Yeti’s biological origins.Current technical limitations, such as qubit stability and hardware capacity, pose challenges to immediate application.Combining quantum tech with improved sequencing and enrichment methods could revolutionize ancient DNA decoding.Ethical and practical concerns must be addressed before quantum computing can definitively solve the Yeti DNA mystery.The Historical Search for the Yeti
The search for the Yeti has captivated explorers and researchers for centuries, driven by reports of mysterious footprints and sightings in the Himalayan mountains. Early expeditions aimed to classify the creature as a cryptid, sparking debates over its legitimacy. Folklore analysis reveals that stories of the Yeti blend local myths with physical evidence, fueling ongoing curiosity. Many believed the Yeti was a yeti-like creature or a spiritual guardian, shaping how explorers approached their quests. Over time, these legends fostered a mix of scientific investigation and cultural storytelling. Despite numerous expeditions and claimed sightings, definitive proof remained elusive. The enduring fascination with the Yeti demonstrates how folklore and cryptid classification keep this mystery alive, inspiring both scientific inquiry and cultural fascination.
Advances in Genetic Analysis and Their Limitations
Recent advances in genetic analysis have revolutionized how researchers approach the Yeti mystery, offering new tools to identify elusive creatures. Genetic sequencing now enables scientists to examine tiny DNA fragments with unprecedented detail, increasing the chances of uncovering authentic evidence. However, data accuracy remains a challenge; contamination, degraded samples, and mislabeling can lead to false conclusions. You might feel hopeful as new techniques improve, but frustration lingers if results are inconsistent. Consider these emotional hurdles:
*The thrill of discovery overshadowed by uncertainty**The frustration of ambiguous or conflicting data**The hope of solving a centuries-old mystery slipping away**The drive to push past limitations despite setbacks*Genetic breakthroughs boost hope but bring frustration amid data uncertainties in the Yeti hunt.
While advances are promising, understanding these limitations is vital in your quest to decode the Yeti’s DNA.
The Promise of Quantum Computing in Genetic Research
Quantum computing holds the potential to revolutionize genetic research by dramatically accelerating data analysis and solving complex problems that are currently beyond reach. With its immense processing power, quantum computers could uncover cryptographic breakthroughs, ensuring data security during sensitive genetic studies. This technology leverages quantum entanglement, enabling instant data transfer and collaboration across research centers. As a result, analyzing vast genetic datasets—like Yeti DNA samples—becomes faster and more precise. Quantum algorithms could identify patterns or mutations hidden within massive genomes, opening new avenues for understanding elusive species. By overcoming current computational limitations, quantum computing offers a promising path to deciphering complex genetic mysteries, including the Yeti DNA puzzle, with unprecedented speed and accuracy.
Potential Methods for Decoding Ancient Yeti Samples
Deciphering ancient Yeti samples requires innovative approaches that combine cutting-edge technology with meticulous sample analysis. To reveal the secrets of ancient DNA, scientists utilize advanced sequencing techniques designed to maximize data retrieval while minimizing sample contamination. Quantum computing offers promising methods, such as enhanced algorithms for analyzing degraded genetic material. You might employ targeted enrichment to isolate ancient DNA segments, reducing contamination risks. Additionally, high-throughput sequencing can provide detailed genetic profiles from tiny samples, increasing accuracy. Cryogenic preservation techniques help prevent further degradation. Combining these methods with quantum algorithms could revolutionize how we decode ancient Yeti DNA, bringing us closer to understanding this mysterious creature. By carefully managing sample contamination and leveraging new tech, you stand at the forefront of this groundbreaking scientific pursuit.
Challenges and Skepticism Surrounding Quantum Applications
You might wonder if quantum computing can truly overcome current scientific hurdles. However, technical limitations like qubit stability and error correction pose significant challenges. Additionally, ethical concerns about manipulating ancient DNA raise questions about responsible research practices.
Technical Limitations PersistDespite the promise of revolutionary breakthroughs, significant technical hurdles still hinder progress in quantum computing. You face formidable obstacles like cryptography challenges, where quantum algorithms threaten existing security protocols. Hardware scalability remains a major issue, making it difficult to build systems powerful enough for complex tasks like decoding Yeti DNA.
You might feel hopeful, but current limitations include:
Fragile qubits prone to errorsLimited coherence times slowing calculationsInsufficient hardware capacity for large-scale problemsUncertainty around overcoming cryptography challengesThese issues create skepticism about quantum’s immediate potential. Until these technical limitations are addressed, quantum computing can’t reliably tackle the complex biological puzzles that remain elusive. The path to decoding the Yeti DNA is still filled with uncertainty and persistent challenges.
Ethical Concerns AriseAs quantum computing advances, ethical concerns and skepticism about its applications grow louder. You might worry about privacy concerns, as powerful quantum algorithms could break existing encryption, exposing sensitive data. This raises questions about data security and individual rights. Additionally, you should consider the environmental impact; quantum computers require significant energy and resources, potentially harming the planet. Critics argue that without proper regulation, these technologies could be misused or cause unintended harm. Skeptics also fear that rapid development might outpace ethical guidelines, leading to misuse or social inequality. As you explore quantum solutions for complex problems like decoding Yeti DNA, it is crucial to balance innovation with responsible practices that address privacy and environmental concerns, ensuring technology benefits society without compromising ethical standards.
Future Prospects: Turning Myth Into Scientific Evidence
Advances in quantum computing are opening new possibilities for DNA analysis, making it easier to verify or disprove mythic claims. You can expect these technologies to transform legends like the Yeti into scientifically testable hypotheses. This shift could finally turn centuries of stories into concrete evidence.
Quantum Advances in DNA AnalysisQuantum computing is poised to revolutionize DNA analysis, transforming long-standing myths into scientific evidence. This leap could open secrets hidden in ancient samples, like Yeti DNA, with unprecedented speed and accuracy. As machine learning integrates with quantum tech, you’ll see breakthroughs in decoding complex genetic data, enhancing genetic privacy and ensuring cryptocurrency security. Imagine a future where:
Genetic privacy risks are minimized through secure quantum encryptionMysterious DNA sequences are identified rapidlyAuthenticity of genetic evidence is verified with certaintyCryptographic protections evolve alongside genetic discoveriesThese advances could finally turn myth into fact, giving you confidence in the authenticity of ancient DNA findings. Quantum’s power promises to reshape forensic science, unlocking mysteries long thought lost to myth and myth alone.
Myth to Scientific ProofThe integration of quantum computing with DNA analysis is set to turn longstanding myths into scientifically verified facts. This breakthrough could resolve cryptozoology debates surrounding creatures like the Yeti, offering concrete genetic evidence to support or challenge folklore validation. Quantum algorithms enable rapid, high-precision sequencing, making it possible to analyze degraded or ambiguous samples that traditional methods struggle with. By doing so, you can move beyond anecdotal stories and folklore, transforming myth into scientific proof. As quantum technology advances, it holds the potential to settle debates once thought impossible to resolve, bringing clarity to legends and confirming or debunking cryptids with unprecedented certainty. This approach paves the way for a new era where scientific inquiry directly addresses myths rooted in folklore.
Frequently Asked QuestionsHow Reliable Are Current Genetic Samples Attributed to the Yeti?You’re right to question the reliability of current Yeti DNA samples. Many samples face issues like contamination or degraded DNA, which compromise data fidelity. This makes it difficult to confirm the authenticity of the samples, as contamination can lead to false positives or misleading results. Without rigorous controls, the genetic data remains uncertain, so you should view current findings with caution until more pristine, verified samples are analyzed.
Could Quantum Computing Distinguish Yeti DNA From Other Primates?You ask if quantum computing can distinguish yeti DNA from other primates. With its advanced processing, quantum tech could improve cryptid identification by rapidly analyzing complex DNA data. This helps in DNA differentiation, making it easier to confirm if samples truly belong to a yeti or a known species. While not a guarantee, quantum computing offers promising potential to uncover the truth behind cryptid mysteries like the yeti.
What Are the Ethical Concerns of Decoding Mythical Creature DNA?You’re walking on thin ice when considering decoding mythical creature DNA. Ethical dilemmas like potential harm, biosecurity risks, and the misuse of genetic data can arise. It’s essential to remember your scientific responsibility to avoid unintended consequences and respect natural boundaries. While revealing secrets can advance science, rushing in without caution risks crossing lines that might lead to unforeseen problems. Always weigh the moral implications before pushing forward.
How Might Quantum Algorithms Improve Ancient DNA Analysis?You can see that quantum algorithms might revolutionize ancient DNA analysis by efficiently decoding cryptic sequences that traditional methods struggle with. Quantum heuristics enable you to process complex genetic data faster, revealing insights obscured by degradation or noise. This could lead to breakthroughs in understanding ancient species, including mythical creatures like the Yeti, by providing more accurate and all-encompassing genetic reconstructions from fragmented DNA samples.
Is There a Risk of Misinterpreting Quantum Data in Cryptid Research?You should be aware that quantum misinterpretation can pose risks to cryptid research, especially regarding data fidelity. If you rely too heavily on quantum algorithms without proper validation, you might draw inaccurate conclusions about elusive creatures like the Yeti. To avoid this, guarantee rigorous verification methods are in place, maintaining high data fidelity and minimizing the chances of quantum misinterpretation, ultimately leading to more reliable findings.
ConclusionIf quantum computing finally cracks the Yeti DNA mystery, you’ll witness a scientific breakthrough that could eclipse all previous discoveries, transforming myth into irrefutable fact. While skeptics warn of insurmountable hurdles, your curiosity fuels the pursuit of truth. This quest isn’t just about decoding ancient genes; it’s about challenging what you thought was impossible. In this moment, the line between legend and science blurs, promising a future where even the most fantastical stories might someday be proven true.
July 20, 2025
The Genetics of Dragon‑Like Creatures: Can CRISPR Bring Them Back?
CRISPR technology makes it theoretically possible to manipulate genes responsible for traits like scales, fire resistance, and wings in reptilian creatures, blending science with myth. Researchers are identifying genetic markers linked to these features, but reconstructing ancient DNA remains challenging due to degradation and contamination. Ethical concerns about ecological impacts and moral implications also arise. If you continue exploring, you’ll discover how future advancements could turn some legends into scientific realities.
Key TakeawaysGenetic analysis of modern reptiles reveals genes responsible for dragon-like traits such as scales, wings, and fire resistance.CRISPR-Cas9 can potentially edit these genes to recreate or enhance mythical features in living organisms.Ancient DNA recovery is challenging but essential for understanding extinct species akin to legendary dragons.Ethical and ecological risks must be considered before attempting to resurrect or engineer dragon-like creatures.While scientifically conceivable, current technology and knowledge are insufficient to fully bring mythical dragons back through gene editing.The Mythical Origins of Dragon-Like Beings
Many cultures have legends of dragon-like creatures, suggesting these beings have deep roots in human imagination. Ancient folklore across the world features dragons as symbols of power, wisdom, and chaos, shaping mythic symbolism that persists today. These stories often reflect cultural values and fears, portraying dragons as protectors or destructive forces. You might notice how such legends serve as allegories, embodying natural elements or human traits. The recurring presence of these creatures in diverse mythologies hints at a universal archetype—an enduring symbol of strength and mystery. By exploring these myths, you connect with a shared cultural heritage that has influenced stories, art, and beliefs for centuries. These legends continue to fuel curiosity about the origins and possible biological basis of dragon-like beings.
Deciphering the Genetic Blueprint of Reptilian Creatures
Revealing the genetic blueprint of reptilian creatures involves analyzing their DNA to understand the biological basis of their unique features. Medieval legends often depict dragons with fiery breath and impenetrable scales, shaping cultural symbolism of power and protection. By studying modern reptiles, you can identify genes responsible for these traits, revealing how ancient stories may mirror real biological adaptations. Comparing genetic sequences across species uncovers evolutionary links, helping you pinpoint genes linked to size, fire resistance, or wing development. This exploration into their DNA bridges myth and science, showing how cultural symbolism reflects biological realities. Understanding these genetic foundations gives you insight into how legendary creatures might have existed and how gene editing could someday recreate aspects of their biology.
Advances in Gene Editing: CRISPR and Its Capabilities
Recent advances in gene editing, particularly the development of CRISPR-Cas9 technology, have revolutionized the way scientists can modify DNA with unprecedented precision and efficiency. You can now target specific genes responsible for traits seen in medieval mythology and fantasy archetypes, such as dragon wings or fire-breathing capabilities. CRISPR’s ability to cut and replace DNA segments allows for precise editing, making the dream of recreating mythical creatures more feasible. Instead of relying solely on speculation, you can manipulate genetic sequences to potentially bring back ancient traits or even extinct species. This technology offers a new level of control, transforming centuries-old legends into scientific possibilities. With CRISPR, the line between myth and reality becomes increasingly blurred, opening doors to extraordinary biological innovations.
Potential Genetic Markers for Dragon-Like Traits
You can identify specific genes responsible for fire breath, scales, wings, claws, and horns in dragon-like creatures. These genetic markers help explain how such remarkable traits develop and vary among species. Exploring these markers opens new possibilities for understanding and potentially modifying dragon-like features.
Genes for Fire BreathScientists are actively searching for specific genes that could enable fire-breathing abilities in dragon-like creatures. In fantasy folklore, fire-breathing symbolizes power and dominance, making it a compelling trait to replicate genetically. Researchers look for genes involved in combustion, thermoregulation, and specialized gland functions, aiming to understand how a creature might produce and safely expel flames. These genetic markers could be linked to proteins that generate intense heat or catalyze chemical reactions, similar to how some animals produce bioluminescence. Recognizing these genes also taps into cultural symbolism, where dragons represent strength and mysticism. Pinpointing the genetic basis for fire breath could someday allow scientists to manipulate or recreate this iconic trait, bridging myth and science in groundbreaking ways.
Scales and Wing DevelopmentHave you ever wondered how the distinctive scales and wings of dragon-like creatures develop? These features carry rich mythical symbolism and cultural significance, shaping how societies view dragons. Genes involved in scale formation, such as those controlling keratin production, are key markers for these traits. Wing development depends on genes influencing limb patterning and tissue growth. Potential genetic markers include:
Keratin-associated genes for scalesMorphogens regulating limb outgrowthTranscription factors guiding tissue differentiationGenes influencing cartilage and bone developmentSignaling pathways like Sonic Hedgehog (SHH)Understanding these markers could reveal how scales and wings form, bridging myth and biology. Such insights might one day enable engineered creatures with iconic dragon traits, reaffirming their deep cultural symbolism.
Claw and Horn FormationBuilding on the understanding of scale and wing development, the formation of claws and horns in dragon-like creatures involves a complex interplay of genetic factors that dictate their unique shapes and structures. These features often carry deep mythical symbolism, representing power, protection, or divine authority. Culturally, claws and horns serve as markers of strength and dominance, influencing how these creatures are perceived across different societies. Genes regulating limb and cranial development, such as those in the Hox family, likely play vital roles. Identifying potential genetic markers for these traits can reveal how such features evolved and how they might be recreated through gene editing. Understanding these markers also helps decode the cultural symbolism embedded in dragon-like anatomy, linking biological traits with their mythological significance.
Challenges in Reconstructing Ancient DNA and Traits
Reconstructing ancient DNA and traits from fossilized remains presents significant hurdles because genetic material degrades rapidly over time. You face difficulties retrieving intact sequences of ancient DNA, which is often fragmented or contaminated. This complicates fossil reconstruction efforts and limits understanding of extinct species. Challenges include:
DNA degradation due to environmental factorsContamination from modern organismsLimited preservation in certain climatesDifficulty distinguishing genuine ancient DNA from noiseIncomplete genetic data hindering accurate trait reconstructionRecovering ancient DNA is hindered by rapid degradation and contamination, complicating efforts to understand extinct species.
These issues make it hard to accurately piece together an organism’s genetic makeup. Without high-quality ancient DNA, recreating traits or understanding evolutionary links becomes nearly impossible, slowing progress in resurrecting or studying extinct creatures like dragons.
Ethical Dilemmas in Resurrecting Mythical Creatures
Resurrecting mythical creatures raises important moral questions about whether we should interfere with nature’s course. You need to contemplate the ecological risks these creatures could pose to existing ecosystems. Are the potential benefits worth the possible consequences?
Moral Implications of RevivalHave you ever considered whether bringing mythical creatures back to life is ethically justifiable? Restoring these beings raises questions about their cultural significance and mythical symbolism. Do we have the right to manipulate nature for entertainment or scientific curiosity? You might ponder whether reviving creatures honors or disrespects their original symbolism.
Respect for cultural traditionsPotential misrepresentation of mythsImpact on existing ecosystemsMoral duty to preserve natural orderRisks of commodification and exploitationWhile some see revival as a way to reconnect with myth, others worry about trivializing their importance. Balancing scientific progress with respect for cultural and moral boundaries is essential in this debate.
Ecological Risks InvolvedBringing mythical creatures back to life can pose serious ecological risks that are often overlooked in ethical debates. Introducing these creatures may disrupt existing ecosystems, causing habitat disruption and threatening native species. You need to contemplate how a revived dragon or similar creature could compete for resources or introduce new diseases. These ecological risks could cascade, destabilizing ecosystems and harming biodiversity. To visualize this, consider the following:
Ecological RisksPotential ConsequencesHabitat disruptionLoss of native species, ecosystem imbalanceCompetition for resourcesDecline of indigenous populationsDisease transmissionSpread of new pathogens, ecological collapseEcological Impacts of Introducing Recreated Dragons
Introducing recreated dragons into existing ecosystems can profoundly alter ecological balances, often with unpredictable consequences. These creatures carry powerful mythical symbolism and cultural representation, which influence human perceptions but also impact nature. Their presence could disrupt food chains, compete with native species, or introduce new diseases. You might see:
Displacement of local predators or preyChanges in plant and animal diversityUnintended spread of genetic traitsDisruption of habitat structuresAltered predator-prey dynamicsRecreated dragons could disrupt ecosystems, threaten native species, and cause unpredictable environmental changes.
While dragons symbolize strength and awe, their ecological integration could lead to unforeseen environmental shifts. The cultural importance of dragons might also drive human activity, further complicating ecosystem stability. You must consider both ecological risks and the broader societal implications before pursuing their recreation.
Future Prospects and Scientific Possibilities
Advancements in genetic engineering and biotechnology are opening new possibilities for the recreation and modification of dragon-like creatures. With recent biotechnological breakthroughs, scientists are exploring how to revive or create these mythical creatures from genetic material or closely related species. CRISPR gene editing offers precise manipulation of DNA, enabling the potential revival of extinct species and the enhancement of traits once thought impossible. Looking ahead, these scientific developments could lead to the revival of mythical creature revival projects or entirely new species with unique characteristics. While still in early stages, future prospects include combining ancient DNA with modern technology to access genetic secrets. Although ambitious, these possibilities push the boundaries of science and imagination, offering a glimpse into a future where dragons and similar creatures might once again take flight.
Balancing Imagination With Scientific Responsibility
As scientists push the boundaries of genetic engineering to recreate mythical creatures like dragons, it becomes essential to take into account the ethical and safety implications of such work. Balancing imagination with scientific responsibility requires careful consideration of potential risks and societal impacts. You must guarantee that creating creatures from fantasy biology aligns with ethical standards and public safety.
Key points include:
Respect for mythical taxonomy and biological diversityAvoiding ecological disruptionPreventing misuse of genetic technologyMaintaining transparency and public engagementPrioritizing animal welfare and safetyFrequently Asked QuestionsCould Resurrected Dragons Have Any Real Biological Functions or Advantages?You wonder if resurrected dragons could have biological advantages or evolutionary significance. While they might develop functions like enhanced flight or fire resistance, these traits could also be disadvantages, such as increased energy needs. Their presence could influence ecosystems, potentially offering insights into adaptive evolution. However, without natural selection, their survival and benefits remain uncertain, making it unlikely they’d hold significant evolutionary importance today.
What Are the Legal Implications of Bringing Mythical Creatures Back to Life?You need to consider the legal implications of bringing mythical creatures back to life, especially around intellectual property rights and regulatory challenges. Laws may not clearly cover such groundbreaking genetic work, leading to disputes over ownership and ethical use. You might face hurdles in obtaining approvals, maneuvering international regulations, and ensuring responsible research. Being aware of these legal aspects helps you prepare for potential conflicts and ethical considerations involved in resurrecting mythical beings.
How Might Public Perception Influence Scientific Research on Dragon Reconstruction?Imagine a double-edged sword swinging over scientific progress. Your public perception, shaped by skepticism and ethical debates, can either propel or hinder dragon reconstruction research. When the public doubts the morality or safety, scientists might face increased scrutiny or restrictions. Conversely, support and enthusiasm can unleash funding and collaboration. Your voice matters—it’s the compass guiding the balance between innovation and responsibility in bringing mythical creatures back to life.
Are There Potential Health Risks Associated With Genetically Recreating Dragons?You should consider that genetically recreating dragons could pose health risks due to genetic instability, which might lead to unforeseen mutations or vulnerabilities. Ethical concerns also come into play, as creating such creatures raises questions about animal welfare and ecological impacts. These factors highlight the importance of thorough research and regulation to ascertain safety and moral responsibility before proceeding with any genetic engineering efforts.
Could Ancient DNA Degradation Prevent Successful Genetic Resurrection of Dragons?Like chasing shadows in a fading sunset, you face ancient DNA degradation challenges when attempting resurrection. Over time, DNA deteriorates, breaking into fragments that hinder accurate sequencing. This degradation limits your ability to reconstruct full genomes necessary for revival. Without intact ancient DNA, even cutting-edge tools like CRISPR stumble, making the successful genetic resurrection of dragons a distant dream, obscured by the relentless march of time’s entropy.
ConclusionSo, while CRISPR might someday bring dragons back from myth to reality, don’t hold your breath—or do, if you want to breathe fire. As you marvel at the scientific marvels, remember: playing god with ancient DNA could turn us into the very monsters we once only feared in stories. Perhaps it’s safer to enjoy dragons in books—less risk of setting the world ablaze with our own fiery ambitions.
July 19, 2025
Will AI One‑Day Simulate Loch Ness Sightings in Real Time?
AI is advancing rapidly and could soon create real-time, immersive Loch Ness sightings that feel just like genuine encounters. Using deep learning, high-quality visuals, and real-time rendering, these simulations might fool even skeptics. As technology evolves, the line between myth and reality could blur, making it harder to distinguish truth from digital illusion. If you’re curious about how this develops further, there’s plenty more to explore.
Key TakeawaysAI technology, including real-time rendering and neural interfaces, could enable simulated Loch Ness sightings in the future.Advances in high-quality visuals and immersive environments make realistic, live-like monster encounters increasingly feasible.Ethical and authenticity challenges remain, requiring robust methods to distinguish simulations from genuine sightings.The blending of myth and technology might lead to convincing virtual experiences, but actual physical sightings are unlikely.Ongoing innovations in AR and VR could make real-time, immersive Loch Ness simulations a common entertainment or educational tool.The Evolution of AI and Its Potential for Cryptid Recreation
As artificial intelligence has advanced, it has become increasingly capable of creating highly realistic simulations, opening new possibilities for recreating cryptids like the Loch Ness Monster. This shift introduces a concept called mythical realism, where digital environments make legendary creatures feel almost tangible. Through AI, you can now generate immersive stories and sightings that blend myth and modern technology, fueling digital folklore. These creations can mimic the creature’s elusive nature, sparking curiosity and debate without actual sightings. As AI continues to evolve, it challenges traditional notions of authenticity, blurring lines between fact and fiction. You might soon find yourself questioning whether a digital recreation is just a simulation or a new form of legendary storytelling—an extension of the myth itself.
Techniques Behind Creating Immersive Digital Sightings
Creating immersive digital sightings relies on a combination of advanced AI algorithms, high-quality visual data, and real-time rendering techniques. You leverage quantum computing to process massive datasets quickly, enabling realistic simulations, while neural interfaces allow direct interaction, enhancing immersion. These technologies work together to generate convincing sightings in real-time, capturing every ripple and movement. To visualize this, consider the following table:
TechniquePurposeKey TechnologyAI AlgorithmsGenerate realistic creature behaviorsDeep learning, neural networksHigh-Quality DataEnsure visual accuracy4K cameras, dronesReal-Time RenderingDisplay seamless, instant visualsGPU accelerationQuantum ComputingHandle complex calculations swiftlyQuantum processorsNeural InterfacesEnable user interaction and controlBrain-computer interfacesChallenges in Authenticating AI-Generated Monster Sightings
Authenticating AI-generated monster sightings presents significant challenges because distinguishing between real and simulated events requires overcoming sophisticated deception techniques. You need to verify data authenticity, which is difficult when AI can produce highly convincing images, videos, or reports. False sightings can be meticulously crafted to mimic genuine evidence, making it hard to tell what’s real. Scientific validation becomes vital but also complicated; experts must analyze the evidence critically and rely on objective criteria. Without clear standards or reliable markers, confirming the legitimacy of sightings remains elusive. The risk of spreading misinformation increases if AI-generated sightings are mistaken for genuine events. Ultimately, you face the challenge of developing robust methods to authenticate data, ensuring that only verified evidence influences public perception and scientific understanding.
Ethical and Cultural Implications of Simulated Mysteries
The rise of AI-generated mysteries raises profound ethical and cultural questions that extend beyond technical challenges. As AI creates realistic simulations of sightings, you must consider how this impacts cultural preservation. Will these artificial stories reinforce existing myths or erode genuine local traditions? There’s a risk of myth fabrication, where fabricated narratives overshadow authentic history, confusing audiences and diluting cultural identity. You might unintentionally contribute to a world where truth becomes blurred, making it harder to distinguish between genuine heritage and simulated stories. Ethical concerns also arise around consent, authenticity, and the potential manipulation of public perception. Balancing technological innovation with respect for cultural integrity is vital, ensuring that AI enhances rather than erodes the rich tapestry of local myths and legends.
The Future of Augmented Reality and Live Virtual Encounters
As augmented reality advances, you’ll experience more immersive, real-time encounters that bring mysteries like Loch Ness to life right before your eyes. This technology boosts visitor engagement, making exploration more interactive and memorable. However, it also raises ethical questions about authenticity and the boundaries of virtual experiences.
Immersive Real-Time ExperiencesImmersive real-time experiences are transforming how you interact with virtual environments, making encounters feel more authentic and engaging. With advanced augmented reality, you become part of mythical storytelling, where digital folklore comes alive around you. These experiences enable you to witness legendary sightings, like Loch Ness, as if they’re happening in real time. You can explore the environment, hear stories from virtual witnesses, and see creatures emerge from the depths, all seamlessly integrated into your surroundings. This technology blurs the line between myth and reality, immersing you fully in the narrative. As a result, you don’t just observe stories—you become a participant in the legend, creating a personal connection that deepens your engagement with these age-old tales.
Enhanced Visitor EngagementEnhanced visitor engagement is rapidly evolving with augmented reality and live virtual encounters that make experiences more interactive and personalized. These technologies allow you to explore Loch Ness’s history and legends firsthand, deepening your connection to the site’s cultural preservation. Virtual overlays can recreate the monster’s sightings or ancient stories, offering a richer understanding of local traditions. This immersive approach boosts the attraction’s appeal, drawing more tourists while preserving the environment and heritage. By integrating AR, you can engage with the site without physical alteration or over-tourism, supporting sustainable tourism practices. Overall, these innovations transform Loch Ness into a dynamic, educational, and enthralling destination, ensuring that its cultural significance endures for future generations.
Ethical Considerations in ARWhile augmented reality transforms how visitors experience Loch Ness, it also raises important ethical questions about authenticity and manipulation. You need to contemplate privacy concerns, especially how data is collected and used during AR interactions. Additionally, issues of intellectual property emerge when creating virtual content—ensuring you don’t infringe on copyrights or misrepresent ownership. To navigate these concerns, keep in mind:
Protect visitor privacy by securing data and being transparent about its use.Respect intellectual property rights when designing or sharing AR content.Maintain authenticity to avoid misleading visitors or creating false impressions.Balancing Skepticism and Wonder in AI-Driven Mythology
As AI-driven mythologies like the real-time Loch Ness sightings emerge, striking a balance between skepticism and wonder becomes essential. You need to appreciate AI creativity’s ability to craft enthralling stories, but also remain cautious about accepting them as proof of mythical authenticity. While AI can generate impressive, immersive experiences that fuel your sense of wonder, it’s crucial to question the origins and accuracy of what you see. Embracing the magic of these digital illusions can inspire curiosity, yet maintaining a healthy skepticism prevents you from falling for falsehoods. This balance allows you to enjoy AI’s storytelling power while critically evaluating its claims, ensuring you don’t lose sight of the line between genuine mystery and simulated myth.
Frequently Asked QuestionsCould AI Recreate Historical Cryptid Sightings That Never Actually Occurred?You might wonder if AI can recreate cryptid sightings that never actually happened. With advanced technology, you can generate realistic scenarios, but cryptid authenticity remains uncertain. While AI can help preserve folklore by visualizing stories, it can’t confirm their truth. Instead, it risks blurring the lines between genuine sightings and fiction, which may impact folklore preservation. Ultimately, AI’s role should be to enhance storytelling without misleading about real cryptid encounters.
How Might Ai-Generated Sightings Influence Public Perception of Real Discoveries?Imagine a child’s belief in Santa fading due to fake photos—that’s how AI-generated sightings could impact your trust. As AI creates convincing but fabricated discoveries, public trust might weaken, and misinformation spreads faster than ever. You could struggle to distinguish genuine findings from false, making it harder to accept real discoveries. This blurring line could ultimately diminish your confidence in scientific evidence and the stories that once inspired wonder.
Will AI Simulations of Cryptids Ever Be Indistinguishable From Genuine Encounters?You wonder if AI simulations of cryptids will ever seem like authentic experiences. While AI can craft incredibly detailed digital authenticity, it’s unlikely these simulations will fully replicate the genuine encounter’s emotional depth and unpredictability. As a result, you may recognize the difference between real sightings and digital illusions, but advancements could blur these lines, making AI-generated encounters feel more authentic—challenging your perception of what’s real and what’s simulated.
What Are the Potential Risks of Spreading False Sightings Through AI Technology?You should consider that spreading false sightings through AI technology risks misinformation spread, which can mislead the public and create false perceptions of reality. If AI-generated cryptid encounters become convincing, they might fuel public misperception, causing people to believe in phenomena that don’t exist. This can undermine trust in genuine evidence, hinder scientific research, and divert attention from real issues, emphasizing the importance of verifying and regulating AI-generated content.
How Can We Ensure AI Recreations Respect Local Cultures and Folklore?To guarantee AI recreations respect local cultures and folklore, you should prioritize cultural sensitivity by involving community voices and experts during development. Incorporate authentic stories and symbols to preserve folklore accurately. Regularly review AI outputs to avoid misrepresentation or cultural insensitivity. This approach helps honor traditions, fosters trust, and ensures that AI tools support folklore preservation rather than distort or diminish it.
ConclusionAs you imagine standing by Loch Ness, watching an AI-generated monster breach the water in real time, it’s like witnessing a modern-day fairy tale come alive. Just as explorers once chased legends with curiosity and caution, today’s technology blurs the line between myth and reality. With each breakthrough, you hold the power to shape a new kind of wonder—one that invites both skepticism and awe, reminding you that some mysteries are worth exploring, even if only in digital dreams.
July 17, 2025
Could Cryptids Colonize Mars? Scientists Map the Possibilities
Scientists explore whether cryptids could survive on Mars by examining their mythical traits and adaptability. While some legends suggest cryptids could develop resilience through specialized senses and camouflage, the planet’s harsh environment presents major challenges like radiation, extreme temperatures, and scarce water. Subsurface ecosystems offer potential hiding spots, but technological and ethical hurdles remain. If you’re curious how myth might meet science, there’s more to uncover about the fascinating possibilities ahead.
Key TakeawaysCryptids’ biological traits, like adaptability and resilience, could theoretically support survival if they evolved or were bioengineered for Martian conditions.Subsurface habitats on Mars might provide suitable environments for cryptids, shielding them from radiation and extreme temperatures.Advanced terraforming and biosynthesis technologies could create habitable ecosystems, potentially enabling cryptid colonization.Ethical concerns and ecological risks of introducing cryptids to Mars pose significant challenges to their hypothetical colonization.The mythological symbolism of cryptids inspires scientific exploration and bioengineering efforts to explore extraterrestrial life possibilities.The Mythology and Origins of Cryptids
Cryptids are creatures whose existence is debated, often rooted in ancient myths, folklore, and local legends. Their mythical origins trace back centuries, shaping stories that blend reality and imagination. You might see cryptid symbolism as representing fears, cultural values, or natural mysteries that early societies couldn’t explain. For example, legendary beings like the Loch Ness Monster or Bigfoot reflect humanity’s fascination with the unknown. These creatures often symbolize more than just stories—they embody cultural identity, fears, and hopes. By understanding their mythical origins, you gain insight into how different civilizations interpreted the world around them. Cryptids serve as symbols of mystery and the enduring human desire to explore what lies beyond known boundaries.
Biological Traits and Adaptability of Cryptids
Many cryptids exhibit remarkable biological traits that enable them to survive in their mysterious habitats, often displaying adaptations that blur the line between reality and myth. These cryptid metaphors symbolize resilience and mystery, rooted in folklore origins that fuel imaginative survival stories. Some cryptids possess extraordinary senses, like heightened hearing or night vision, allowing them to navigate hostile environments unseen. Others have evolved durable skins or camouflage techniques, making them nearly invisible—traits that could theoretically aid in extraterrestrial survival. Their biological traits reflect a capacity for rapid adaptation, blending mythic qualities with potential biological plausibility. This versatility suggests that, if cryptids existed, their adaptability might enable them to survive in extreme environments like Mars, where resilience is essential for long-term colonization.
Environmental Conditions on Mars and Their Challenges
Mars’s surface is full of hazards, from its rocky terrain to dust storms that can strike without warning. The thin atmosphere offers little protection and makes breathing difficult, forcing you to find or create reliable resources. Understanding these environmental challenges is vital for cryptids to survive and thrive on the Red Planet.
Surface Composition and HazardsHave you ever wondered what makes the Martian surface so hostile to life and exploration? The terrain is a relentless mix of sharp, rocky landscapes, fine dust, and corrosive chemicals that erode equipment and hide hazards. Cryptid folklore often describes creatures with mythical resilience, capable of surviving extreme conditions, but Mars challenges even the toughest legends. Its surface contains perchlorates and heavy metals, which pose serious health risks and complicate colonization efforts. The dust storms can blanket the planet for weeks, reducing visibility and damaging machinery. These hazards demand advanced protective measures for any hypothetical cryptid explorers. Understanding the surface composition helps identify potential safe zones, but the hostile environment remains a significant barrier to survival—legend or not.
Atmospheric Challenges and ResourcesAlthough the atmosphere on Mars is thin and composed mainly of carbon dioxide, it presents significant challenges for any form of life or exploration. The lack of oxygen and extreme temperatures threaten cryptid habitats and mythic evolution. Without a stable atmosphere, sustaining life becomes nearly impossible. You face a hostile environment where resources are scarce, and survival hinges on technological adaptation. Consider this:
ChallengeImpactSolutionThin, CO2-rich atmosphereBreeds suffocation, limits respirationTerraforming or sealed habitatsExtreme temperaturesCauses structural stress, energy drainInsulation, energy sourcesLimited water resourcesRestricts life support systemsIce mining, recyclingThese atmospheric hurdles test the mythic resilience of cryptids, threatening their habitat and evolution on Mars.
Possibility of Cryptid Survival in Martian Atmospheres
You might wonder if cryptids can survive Mars’s thin, unbreathable atmosphere. Their ability to resist extreme conditions depends on how well they adapt to low pressure and limited oxygen. Exploring their potential resilience could reveal surprising survival strategies.
Atmospheric Adaptation ChallengesCould cryptids realistically survive in the thin, harsh atmosphere of Mars? Considering their cryptid folklore and mythological origins, survival seems unlikely without major adaptation. Mars’ atmosphere is mostly carbon dioxide, with trace amounts of oxygen, making breathing difficult. Cryptids from Earth’s legends often rely on environments with breathable air and stable weather patterns. Their mythological origins suggest they evolved in conditions vastly different from Mars, so adapting to its extreme cold, radiation, and low pressure would be a significant challenge. Without biological changes or technological support, their natural resilience would be insufficient. The atmospheric adaptation challenges highlight just how incompatible Earth-based cryptids are with Martian conditions, emphasizing that myth and folklore alone can’t guarantee their survival on a planet so fundamentally different.
Potential Cryptid ResilienceWhile the harsh conditions of Mars pose significant hurdles, some cryptids might possess inherent traits that could give them a slim chance of survival. Drawing from cryptid folklore and mythological origins, these creatures often exhibit resilience beyond natural limits. Their legendary adaptability might allow them to endure extreme environments, including low pressure and radiation.
You might imagine cryptids with:
*Unbreakable biological armor* that shields against radiation*Superhuman regenerative abilities* for rapid healing*Unusual metabolic processes* that thrive on minimal resources*Mystical camouflage* to hide from hostile surroundings*Ancient mythological origins* hinting at survival through supernatural meansWhile speculative, these traits could give cryptids a fighting chance, fueling hope that some legendary beings might endure beyond Earth.
Potential for Cryptids to Thrive in Subsurface Ecosystems
Subsurface ecosystems on Mars could offer cryptids a surprisingly stable environment, shielded from harsh surface conditions like radiation and extreme temperatures. These hidden habitats might support cryptid ecology by providing consistent warmth, moisture, and nutrients, making survival feasible. Since many folklore origins describe cryptids living in remote, underground areas, it’s plausible that similar ecosystems could sustain them on Mars. The darkness and isolation could mimic the environments linked to legends of mysterious creatures lurking beneath the earth. If cryptids evolved or adapted to underground habitats on Earth, they might have the resilience needed to thrive in Martian subsurface environments. This potential underscores how such ecosystems could serve as refuges, enabling cryptids to persist beyond surface challenges and supporting the idea of their extraterrestrial survival.
Genetic Engineering and the Idea of Cryptid Introduction
Advances in genetic engineering open the possibility of introducing cryptids to extraterrestrial environments like Mars, transforming speculative ideas into feasible experiments. With modern techniques, you could modify DNA inspired by cryptid mythology to create resilient creatures suited for alien worlds. This approach sparks excitement and fear, challenging your understanding of life’s boundaries. Consider these emotional impacts:
Awe at bringing mythical creatures into realityAnxiety over unforeseen ecological consequencesWonder about rewriting biology itselfCuriosity about bridging myth and scienceEthical dilemmas of playing godEthical and Scientific Considerations of Interplanetary Colonization
As humanity pushes forward with interplanetary colonization, ethical and scientific considerations become increasingly critical. You must weigh the implications of introducing cryptid mythology into new ecosystems, questioning whether it’s right to alter extraterrestrial environments with potentially unknown life forms. Interstellar ethics demand that we respect the intrinsic value of any native or cryptid-like life, avoiding harm or unintended consequences. Scientific considerations involve understanding the biological complexities and risks of integrating cryptids into Mars’s environment, ensuring we don’t cause irreversible damage. Balancing curiosity with responsibility is essential. As you contemplate colonization, remember that your decisions could set precedents for respecting extraterrestrial life, challenging you to act ethically while pushing the boundaries of scientific discovery.
Comparing Earth’s Ecosystems and Martian Environments
Earth’s ecosystems are highly diverse and finely balanced, supporting a wide array of life forms through complex interactions and stable conditions. On Mars, environments are harsh—dominated by extreme temperatures, radiation, and scarce water—making survival challenging. This stark contrast influences cryptid mythology, fueling speculation about mysterious creatures lurking in Earth’s rich habitats, unlike anything possible on Mars. When considering cryptid biology, Earth’s varied ecosystems nurture unique adaptations not feasible on the Red Planet’s barren surface.
Feel a sense of wonder at Earth’s vibrant life versus Mars’s desolationImagine cryptids thriving in lush, protected habitats, unlike barren landscapesContemplate how environment shapes cryptid evolution and mythologyRecognize the importance of ecological stability for diverse lifeConsider how alien environments challenge our understanding of cryptid biologyTechnological Advances That Could Support Exotic Life FormsEarth’s diverse, stable ecosystems foster unique cryptid adaptations unseen on Mars’s barren, extreme landscape.

You’ll need cutting-edge terraforming innovations to create a hospitable environment for cryptids and other exotic life forms. Advanced biosynthesis techniques can generate essential nutrients and materials, supporting their survival amid harsh conditions. Together, these technologies could turn Mars into a viable new home for life beyond Earth.
Terraforming Innovations Enable SurvivalRecent technological advances in terraforming are opening new possibilities for supporting exotic life forms on Mars. These innovations could enable cryptid folklore and creatures of mythical origins to survive beyond Earth. Imagine harnessing atmospheric processors that create habitable zones, or bio-domes that mimic Earth’s environments perfectly. You might see genetically engineered organisms designed to thrive in Martian soil, blurring the line between myth and science. These breakthroughs could turn Mars into a haven for legendary beings long thought to be only stories. The thrill of encountering cryptids in new worlds fuels curiosity and adventure.
Creating oxygen-rich atmospheres that sustain lifeDeveloping resilient bio-domes for safe habitatsEngineering plants to adapt to Martian conditionsUsing energy sources to support exotic ecosystemsPreserving mythical origins in a new frontierAdvanced Biosynthesis TechniquesAdvanced biosynthesis techniques are transforming the way we can support exotic life forms on Mars by enabling the precise creation of complex biological molecules in controlled environments. These innovations could help recreate mythical creatures or cryptid origins, giving them a biological foundation suited for extraterrestrial life. By manipulating genetic sequences, you can engineer organisms with unique traits, like resilient skin or energy-efficient metabolisms, supporting cryptid survival beyond Earth. Imagine a table illustrating these possibilities:
TraitFunctionEnhanced resilienceSurvives harsh Martian conditionsBioluminescenceCommunicates in darknessAdaptive metabolismUses scarce resources efficientlyThis technology opens the door to designing life forms that blend myth and science, pushing the boundaries of what’s biologically possible on Mars.
Speculative Scenarios: From Folklore to Future Space Missions
While folklore often sparks curiosity about mysterious creatures, imagining them settling on Mars pushes the boundaries of both science and storytelling. You might wonder how cryptid folklore and mythological creatures could inspire future space missions or influence our view of extraterrestrial life. These stories evoke a sense of wonder and challenge scientific norms, blurring lines between imagination and possibility. Could legends of elusive beings inspire bioengineering efforts or habitat designs? Or spark debates about the ethical implications of encountering unknown life forms? As you consider these scenarios, think about:
The emotional power of mythological creatures inspiring innovationFolklore shaping new scientific hypothesesThe potential for cryptids to symbolize uncharted territoriesHow stories might influence our approach to extraterrestrial explorationThe blend of myth and science transforming future missionsFrequently Asked QuestionsCould Cryptids Adapt Genetically to Survive Extreme Martian Conditions?You wonder if cryptids could adapt genetically to survive Mars’s harsh environment. While genetic engineering might help, natural adaptation strategies are limited by the extreme conditions. Cryptids would need significant genetic modifications to handle radiation, low temperatures, and scarce resources. Although fascinating, the reality is that without advanced biotech, these creatures wouldn’t easily survive or thrive on Mars, making their colonization highly unlikely with current technology.
What Specific Cryptid Species Are Most Likely to Colonize Mars?You might wonder which cryptid species are most likely to colonize Mars. Considering cryptid habitat and behavior, creatures with adaptable, resilient traits could thrive. For instance, cryptids that prefer underground or rocky environments might find suitable shelter, while those with minimal food needs and low activity levels could survive harsh conditions. These traits increase their chances of enduring Mars’ extreme environment, making them the most probable cryptids to establish a new habitat there.
How Would Cryptids Impact Potential Martian Ecosystems?Did you know that introducing cryptids could drastically alter martian ecosystems? Their cryptid behavior, such as unique feeding habits or social structures, might disrupt the delicate ecosystem balance. If cryptids adapt to Mars, they could compete with native microbes for resources or create new ecological niches. Understanding these impacts helps scientists assess risks and benefits, ensuring that any potential colonization supports a sustainable and balanced environment on the Red Planet.
Are There Existing Technologies Capable of Supporting Cryptid Life on Mars?You might wonder if current technologies can support cryptid life on Mars. While terraforming techniques aim to modify the planet’s environment, they’re still in early stages. Scientists are also studying extraterrestrial microbiomes to understand potential life forms. Although we lack specific methods for cryptids, advancements in these areas could eventually create habitats suitable for unknown or mythical creatures, making Mars a more accommodating environment in the future.
What Are the Legal Implications of Introducing Terrestrial Cryptids to Mars?You need to contemplate space law and ethical considerations before introducing terrestrial cryptids to Mars. Space law, like the Outer Space Treaty, emphasizes protecting extraterrestrial environments, so introducing cryptids could violate these regulations. Ethically, you must weigh potential ecological impacts and the moral responsibility of preserving Mars’s existing conditions. You’d be responsible for ensuring that your actions don’t harm potential Martian life or compromise future scientific research.
ConclusionAs you ponder the legends and the science, remember that venturing to colonize Mars with cryptids isn’t just a leap of faith but a journey into the unknown, like Galileo gazing through his telescope into uncharted skies. While your imagination might conjure mythical beasts roaming alien caves, the reality demands cutting-edge tech and ethical debates. So, as you stand on this precipice, keep your eyes on the horizon—history’s pages may soon reveal what lies beyond our world.
January 29, 2025
RANKED: These American Cities Are CRAWLING With Spirits – Your Town Made The List!
If you're intrigued by ghostly tales, you're in luck! America's most haunted cities, like Savannah, New Orleans, and Gettysburg, are crawling with spirits and chilling stories. In Savannah, the ghostly boy at Mercer-Williams House haunts its halls, while New Orleans offers haunting sights in the vibrant French Quarter. Gettysburg reveals tales of fallen soldiers at its historic battlefield. Each city has unique tours, letting you experience the supernatural firsthand. And who knows, you might even discover your town on the list as you explore these paranormal hotspots further!
Key TakeawaysSavannah, Georgia, is renowned for its ghost tours and haunted sites like Mercer-Williams House and Marshall House, steeped in chilling history.New Orleans, Louisiana, boasts deep connections to voodoo practices and ghostly hotspots, particularly in the historic French Quarter.Salem, Massachusetts, captivates with its infamous Witch Trials, featuring haunted locations like the Witch House and educational tours on witchcraft hysteria.Charleston, South Carolina, shares eerie tales of Civil War spirits and the haunting legacy of its history as a slave port.Gettysburg, Pennsylvania, is known for its Civil War hauntings, with sightings of phantom soldiers and eerie encounters at Farnsworth House Inn.Overview of Haunted CitiesWhen you think of haunted cities, several American locations come to mind, each steeped in history and ghostly tales. These cities, rich in historical significance, often harbor ghost stories that echo the events of the past.
You'll find that geological features, like magnetic fields and fault lines, can enhance paranormal activity, making certain haunted spots particularly intriguing.
Take St. Augustine, Florida, for example, the oldest city in the U.S. Here, numerous historic sites contribute to its extensive ghost stories and sightings.
New Orleans, Louisiana, is another prime location, known for its vibrant culture and voodoo traditions. The French Quarter and St. Louis Cemetery No. 1 are hotspots for those seeking the supernatural.
Savannah, Georgia, also ranks high on the list of haunted cities, with a notable reputation for paranormal activity. Its historic homes and cemeteries draw in ghost tours enthusiastic to share tales of the restless spirits that linger.
As you explore these haunted cities, you'll uncover layers of history and mystery, inviting you to experience the spectral side of America.
Top Haunted Cities in America
Across the United States, several cities stand out for their haunted reputations, each offering unique experiences for those intrigued by the supernatural.
Savannah, Georgia, often ranks as the second most haunted city, drawing visitors to its Southern Gothic architecture and ghost tours at historic sites like the Mercer-Williams House and the Marshall House, a former Civil War hospital.
New Orleans, Louisiana, mixes rich history with voodoo culture, where spirits are said to roam St. Louis Cemetery No. 1 and the Le Petit Théâtre. The vibrant atmosphere adds a thrilling backdrop to these ghostly encounters.
Salem, Massachusetts, infamous for the Salem Witch Trials, invites you to explore its dark past through educational tours and memorials. The Witch House remains the last standing structure connected to the trials.
Charleston, South Carolina, carries a haunted reputation tied to its history as a major slave port. Ghost sightings at Boone Hall Plantation and the Old Jail reflect the city's complex past.
Spotlight on St. Augustine
When you step into St. Augustine, you're walking through the oldest city in the U.S., where history and hauntings intertwine.
You'll encounter ghostly tales tied to significant locations like the Castillo de San Marcos and the St. Augustine Lighthouse.
As you explore, keep an eye out for spirits like Delores, who may still linger among the historic sites.
Historical Significance of HauntingsSt. Augustine, Florida, holds the title of the oldest city in America, and its extensive history makes it a prime haunted city. Founded in 1565, its past is steeped in ghost tales that enchant both residents and visitors. The porous limestone geography contributes to the belief that spirits can easily wander, enhancing the city's reputation for paranormal activity.
Historic landmarks, particularly the Castillo de San Marcos, are focal points for these ghostly encounters. Here, you might hear stories of soldier spirits and even a tragic love triangle that left its mark on the living. One of the most notable spirits is Delores, the ghost of a colonel's wife, whose story adds depth to the city's haunted lore.
The St. Augustine Lighthouse also contributes to the city's ghostly narrative, with tales of a former caretaker and two children who continue to roam its grounds.
The combination of rich history, significant landmarks, and geological features creates a unique environment for supernatural experiences. In St. Augustine, the past isn't just remembered; it's felt, making it a mesmerizing destination for anyone intrigued by the paranormal.
Notable Ghostly EncountersIn the heart of St. Augustine, Florida, the oldest city in the U.S., you'll discover a treasure trove of ghostly encounters. This historic locale is steeped in tales of haunted sites and restless spirits. The Castillo de San Marcos, a renowned fort, is home to soldier ghosts and the poignant story of Delores, a colonel's wife who wanders the grounds in search of her lost love.
Another famous site is the St. Augustine Lighthouse, where visitors report sightings of a former caretaker and the spirits of two children who tragically drowned nearby. The city's porous limestone geology is believed to enhance these hauntings, allowing spirits to roam freely.
Here's a quick look at some notable ghostly encounters in St. Augustine:
LocationNotable Ghostly EncounterCastillo de San MarcosDelores, the colonel's wifeSt. Augustine LighthouseGhost of a former caretakerCastillo de San MarcosSoldier spirits from past conflictsThese encounters are just a glimpse into the haunted history of St. Augustine, where the spirits of the past linger, waiting to share their stories.
Haunted Locations to ExploreExploring the haunted locations of St. Augustine is a spine-tingling adventure you won't want to miss. Known as the oldest city in the U.S., its porous limestone geography is believed to enhance its supernatural reputation.
From eerie historic sites to haunted hotels, there's plenty to discover.
Castillo de San Marcos: Encounter soldier spirits and learn about a legendary love triangle.St. Augustine Lighthouse: Visitors have reported sightings of Delores, the colonel's wife, roaming the grounds.Old Jail: Explore the dark history of former inmates who are said to be haunted.To dive deeper into the city's ghostly tales, join one of the annual ghost tours. These tours provide an immersive experience, taking you through St. Augustine's most haunted spots while sharing fascinating stories.
You'll learn about the spirits that linger, making each location come alive with history. Whether it's the chilling atmosphere of the haunted hotels or the ghostly encounters at historic sites, St. Augustine offers a unique blend of history and the paranormal that's sure to leave you enchanted.
Get ready for a spooky exploration!
New Orleans: A Ghostly Wonderland
New Orleans stands out as a ghostly wonderland, enchanting visitors with its rich tapestry of history and vibrant culture intertwined with supernatural tales. Established in 1718, this city is renowned for its deep connections to New Orleans voodoo, intriguing those curious about its mystical traditions.
The French Quarter serves as a hotspot for ghost sightings, where you can begin on haunted tours that reveal chilling stories of the past. One highlight is St. Louis Cemetery No. 1, the final resting place of the infamous Voodoo Queen, Marie Laveau. Here, legends come alive, and you might feel the presence of spirits lingering among the tombs.
As you stroll through historic streets, keep an eye out for the ghost of a former actress at Le Petit Théâtre, who tragically fell to her death, adding to the city's supernatural lore.
The unique blend of historical tragedies, including wars and murders, fuels a plethora of ghost stories that enhance New Orleans' haunted reputation. Join the throngs of tourists enthusiastic to explore this eerie past and experience the ghostly charm that makes New Orleans truly one of a kind.
Savannah's Haunting Charm
Savannah's haunting charm captivates countless visitors with its Southern Gothic architecture and spine-tingling stories. This city, established in 1733, is renowned as one of America's most haunted locations, thanks to its rich history and eerie atmosphere.
The infamous book "Midnight in the Garden of Good and Evil" showcases Savannah's ghostly lore, drawing many to explore its haunted streets.
You might want to check out some of these infamous sites:
The Mercer-Williams House, where a ghostly boy has been spotted roaming the halls.The Marshall House, a former Civil War hospital with a reputation for paranormal activity.Savannah's haunted squares, built on unmarked graves, reflecting the city's dark legacy.As you investigate the city's past through ghost tours and historical walking excursions, you'll discover why it's considered one of the best haunted cities in America.
Each corner whispers stories of its spectral residents, making your visit both thrilling and unforgettable. Whether you're a ghost enthusiast or simply curious, Savannah promises a supernatural experience that lingers long after you've left its cobblestone streets.
Historical Haunts of Gettysburg
When you walk through Gettysburg, you can't help but feel the weight of its history, especially from the Civil War.
Haunted battlefield tours reveal chilling ghost sightings and echoes of cannon fire that still resonate in the air.
Whether you're visiting the Farnsworth House Inn or exploring Gettysburg College, you're in for a spine-tingling experience.
Civil War Ghost SightingsGettysburg stands as a haunting reminder of the Civil War's ferocity, where the echoes of battle linger long after the guns fell silent. With around 51,000 soldiers killed, wounded, or missing, the site has become a hotspot for ghost sightings and paranormal activity.
As you wander the historic streets, you might encounter the restless spirits of soldiers reenacting their final moments.
Witness apparitions on the battlefield, where phantom cannon fire fills the air.Explore the Farnsworth House Inn, a former Civil War hospital, known for its eerie encounters and unexplained noises.Visit Gettysburg College, where spirits of soldiers are rumored to linger in the halls.Ghost tours in Gettysburg guide you through the town's haunted history, revealing the tragic past that contributes to its supernatural allure.
You'll hear stories that make the hair on your neck stand up, as visitors recount their chilling experiences.
Whether you're a skeptic or a believer, the haunting tales of Gettysburg's Civil War ghost sightings will leave you questioning what truly lingers in the shadows of history.
Haunted Battlefield ToursAs dusk settles over the historic battlefield, the air thickens with stories of bravery and tragedy, drawing you into the eerie world of haunted battlefield tours in Gettysburg. This site, marked by the largest battle of the Civil War, saw approximately 51,000 soldiers killed, wounded, or missing, earning its reputation as a hotspot for spirits and ghostly encounters.
On guided ghost tours, you'll hear chilling tales of spectral soldiers wandering the grounds, often accompanied by phantom cannon fire echoing in the distance. The Farnsworth House Inn, a favorite for visitors, is notorious for its own ghostly sightings, adding to the thrill of your exploration.
During reenactments, you might even catch a glimpse of ghostly figures that seem to step right out of history, blurring the lines between past and present.
Gettysburg College, once a field hospital, is another location brimming with paranormal activity, with reports of ghostly apparitions and strange sounds.
These haunted battlefield tours provide a unique blend of history and legend, enriching your experience as you traverse the hallowed grounds where so many once fought and fell.
Enigmatic Salem and Its Spirits
Salem, Massachusetts, is a town steeped in mystery and haunted by its past, making it an enchanting destination for those fascinated by the supernatural. Known primarily for its dark history of witchcraft, Salem draws visitors eager to uncover the spirits that still linger from the infamous trials of the late 1600s.
When you explore Salem, you'll encounter:
The Witch House, the last standing structure connected to the trials, where Judge Jonathan Corwin lived.Memorials like the Salem Witch Trials Memorial and Proctors Ledge, which honor the victims and encourage reflection.Educational tours and reenactments that investigate the hysteria and societal impact of the witch trials.You can almost feel the weight of history as you walk the cobblestone streets, with stories of those wrongfully accused echoing in the air.
Tales of spirits roaming the Witch House and other sites bring a chilling allure, engaging your imagination.
Salem's connection to literature, such as Nathaniel Hawthorne's "The House of the Seven Gables," further cements its legacy.
If you're seeking a place where history and the supernatural intertwine, Salem is a must-visit.
Unique Ghost Tours Across America
Across the United States, ghost tours offer a thrilling way to explore the haunted histories of various cities.
In Savannah, Georgia, you can wander through the eerie Mercer-Williams House, where a ghostly boy is said to roam, linked to a tragic event.
New Orleans, famously one of the spookiest cities, showcases voodoo practices during its ghost tours, taking you through St. Louis Cemetery and Le Petit Théâtre, revealing the city's supernatural ties.
Traveling to Salem, Massachusetts, you'll find educational tours that dive deep into witchcraft, visiting the Witch House and memorials dedicated to the victims of the infamous trials.
Charleston, South Carolina, invites you to explore its haunted past with walking tours that share spine-tingling tales of Civil War spirits and the ghosts of enslaved people who once lived there.
Frequently Asked QuestionsHow Many Ghost Cities Are in America?There are dozens of cities across America known for their ghostly encounters. While it's hard to pinpoint an exact number, many towns offer rich histories that attract those intrigued by the supernatural.
Which US State Is Considered the Most Haunted?You might find Louisiana, particularly New Orleans, to be the most haunted state in the U.S. Its rich history, vibrant culture, and numerous ghost stories make it a hotspot for paranormal enthusiasts and thrill-seekers alike.
Which Country Has the Most Ghosts?You might think the United Kingdom, with its castles and ghost stories, holds the most spirits. Yet, Japan's yokai and yurei haunt its folklore, while the U.S. boasts cities teeming with restless souls, too.
What State Has the Most Haunted House Attractions?If you're looking for haunted house attractions, California's your best bet. With the iconic Winchester Mystery House and numerous eerie spots, it offers an unforgettable experience for thrill-seekers and ghost enthusiasts alike.
ConclusionSo, whether you're meandering through the moss-draped streets of Savannah or exploring the eerie echoes of Gettysburg, these cities promise a paranormal playground. With their rich histories and ghostly tales, each locale invites you to immerse yourself in its spirited stories. So grab your ghost-hunting gear, gather your friends, and get ready for an unforgettable adventure that'll send shivers down your spine. Who knows what spectral surprises await you in these haunted havens?
January 11, 2025
What if Extensive Cave Systems Hide Evidence of Monsters
Extensive cave systems might just hide secrets and evidence of creatures that challenge your understanding of the natural world. Explorers often share tales of strange sightings, which add to the allure of these mysterious underground domains. Fossils from ancient beasts hint at the connection between folklore and real-life monsters. Unique ecosystems thrive in these dark environments, showcasing life forms adapted to extreme conditions. As explorers face the challenges of traversing these uncharted areas, they could uncover groundbreaking discoveries. Who knows what could be lurking in the shadows? Keep exploring, and you'll uncover even more fascinating insights.
Key TakeawaysExtensive cave systems may harbor undiscovered species, potentially linking ancient fossils to legendary monsters in cultural narratives.Fossil evidence of prehistoric giants, like woolly mammoths and giant ground sloths, may inspire tales of cave-dwelling creatures.Unique adaptations of cave-dwelling organisms, such as olms, demonstrate survival strategies that could be misconstrued as monstrous traits.Ongoing scientific research and eDNA analysis could uncover unknown organisms, validating claims of elusive creatures or cryptids.Legends of monsters often reflect societal fears and anxieties, possibly rooted in real encounters with unusual cave fauna.The Allure of Hidden Worlds
When you think about the vast, uncharted territories beneath our feet, it's easy to feel a tingle of excitement. These extensive cave systems spark intrigue, igniting your curiosity about what lies hidden deep within.
Cultures worldwide have woven legends of mysterious creatures, like the olms, often dubbed "cave dragons," emphasizing the fascination with life forms that thrive in darkness.
Explorers and adventurers frequently share tales of strange sightings, adding layers to the mystique of these underground domains. The interconnectedness of ancient myths and archaeological discoveries, such as Cappadocia's underground cities, raises tantalizing questions about undiscovered species lurking in the shadows.
You can't help but ponder what other secrets may be hidden deep within these caverns. The blend of literature and folklore further fuels your imagination, urging researchers and thrill-seekers alike to explore into the depths.
Each expedition into these enigmatic worlds could lead to groundbreaking discoveries, revealing not only biological mysteries but also illuminating the historical narratives intertwined with these subterranean labyrinths.
The allure of hidden worlds captures your spirit, making every descent an adventure filled with potential wonders waiting to be uncovered.
Legends of Underground Creatures
Exploring the depths of cave systems not only reveals geological wonders but also discloses a rich tapestry of legends surrounding underground creatures.
Thousands of years ago, cultures like the Olm brought forth tales of elusive beings like the cave dragon, often linked to the majestic dragons of their lore. In the Grand Canyon, whispers of hidden tunnels inhabited by mysterious creatures spread through tales of strange encounters, igniting imaginations about what might lurk just beyond our sight.
Traveling to the Caves of Lake Titicaca, you'll hear stories of lost underground cities and the enigmatic beings believed to guard them, reflecting the Tiahuanaco culture's rich history.
Meanwhile, Malta's Ħal Saflieni Hypogeum is woven into myths of ancient rituals and shadowy figures, illuminating how deep-rooted these legends are in human history.
As explorers venture into uncharted cave systems, the prospect of undiscovered monsters becomes tantalizing.
These legends of underground creatures blend the thrill of discovery with the echoes of the past, reminding you that beneath the surface, there may be more than just stone and shadow waiting to be disclosed.
Myths and Cultural Narratives
Many cultures weave fascinating tales around hidden beasts that lurk within cave systems.
These monsters often symbolize deeper fears and societal anxieties, reflecting what people find unsettling about the unknown.
Legends of Hidden BeastsLegends of hidden beasts populate cultures around the world, each narrative revealing humanity's fascination with the unknown.
You might find yourself captivated by the tale of Mokele-Mbembe, a dinosaur-like creature rumored to dwell in the Congo's waterways and caves. Similarly, in Scotland, the Selkie—half seal, half human—transforms and disappears into the mysterious underwater caves, sparking tales of its elusive nature.
Traveling to Latin America, you'll encounter the Chupacabra, a strange creature that haunts caves and abandoned mines, leaving behind bloodless livestock. This fuels fears and stories about its monstrous presence.
Indigenous peoples of North America share the legend of Kachina spirits, believed to inhabit underground domains and embody nature's forces, sometimes appearing as fearsome creatures.
Even in New Zealand, the Māori speak of the Taniwha, a guardian or terror lurking in deep waters or caves, protecting sacred sites.
Each of these legends not only showcases strange creatures but also highlights how deeply rooted these narratives are in human culture, reminding us of the mysteries that lie beneath the earth's surface.
Cultural Symbolism of MonstersThroughout history, monsters in various cultures have served as powerful symbols reflecting our deepest fears and insecurities. For millions of years, these mythical beings have inhabited our stories, often emerging from the dark recesses of cave systems. They represent the unknown, embodying the chaos and struggles that lie within us.
In contemporary society, the rise of technology has also altered how we perceive and communicate these fears, with humor often bridging generational gaps through playful storytelling and shared experiences, similar to how seniors engage in humor over texting.
The Nuckelavee warns of the dangers of unchecked emotions.The Chupacabra evokes fears of the unseen threats lurking in shadows.The Minotaur illustrates our battles with inner demons and the labyrinth of the mind.The Bunyip embodies the dread of the dark and the mysteries of nature.These legends show how the cultural symbolism of monsters transcends time, reflecting societal anxieties. They serve as reminders of the primal fears we all share, whether it's the fear of the dark or the uncertainty of hidden knowledge.
As you explore these narratives, consider how these monstrous figures resonate with your own experiences. They're not just tales of horror; they're mirrors to our psyche, urging us to confront the fears that dwell within the caves of our minds.
Fossils and Evidence of Monsters
Fossils unearthed from ancient cave systems reveal a fascinating connection between prehistoric giants and the monsters of folklore. When you examine the remains of colossal creatures like the Megalonyx, or giant ground sloth, it's easy to see how their immense size could inspire tales of cave-dwelling beasts.
The discovery of perfectly preserved Ice Age mammals, such as the woolly mammoth and cave bear, demonstrates that large, formidable fauna once roamed these dark spaces, potentially fueling legends about lurking monsters.
You might consider the smilodon, or saber-toothed cat, whose fossils found in caves suggest a predatory nature that early humans may have perceived as monstrous. Additionally, the remains of the Irish elk, towering at around 7 feet with antlers spanning 6 feet, certainly evoke images of terrifying giants.
Even extinct species like the thylacine and elephant birds stir the imagination, hinting at hidden monsters in these extensive cave systems.
These fossils don't just tell us about the past; they also bridge the gap between reality and myth, making you wonder just how much these ancient giants influenced the folklore we still share today.
Unique Ecosystems in Caves
Cave ecosystems boast a remarkable array of life forms, each uniquely adapted to the challenges of complete darkness. Here, you'll find species like the olm, thriving in a world that demands specialized feeding strategies and low metabolic rates to survive on limited resources.
These unique ecosystems aren't just fascinating; they're incredibly biodiverse, often showcasing life forms as varied as those found in tropical forests.
Adaptations to low light and nutrient scarcityUnique feeding strategies, relying on detritus and other organismsLong-lived species like the olm, which can reach up to 70 yearsBiodiversity that rivals surface ecosystemsHowever, these ecosystems are delicate. Pollution and habitat disruption pose significant threats, endangering unique species and their intricate habitats.
Recent advancements in environmental DNA (eDNA) techniques have opened new doors for monitoring these subterranean worlds, allowing scientists to detect genetic material in water samples without intruding on fragile environments.
Cave Dragons and Their Biology
When you explore the world of cave dragons, or olms, you'll notice their incredible adaptations, like small limbs and translucent skin, that help them thrive in darkness.
These unique creatures play an essential role as apex predators, maintaining biodiversity in their underground ecosystems.
However, they face numerous threats that could disrupt their delicate balance in these hidden habitats.
Unique Adaptations of OlmsDeep within the dark recesses of Europe's caves, olms, or cave dragons, showcase remarkable adaptations that allow them to thrive in such extreme environments.
These unique adaptations make them fascinating creatures that have evolved specifically for life underground.
Olms can grow up to 12 inches long and live for an impressive 70 years.Their small limbs and translucent skin help them navigate through tight spaces and blend into their surroundings.Juvenile olms have eyes that regress during development, covered by a skin flap, which highlights their complete reliance on dark habitats.With a low metabolism, olms can survive for years without food, illustrating their incredible resilience in nutrient-scarce conditions.These features not only enable olms to endure in the depths of caves but also place them at the top of the cave food chain.
Their ability to adapt to such harsh environments emphasizes the intricate balance of subterranean ecosystems.
Ecological Role in CavesOlms play an essential ecological role within their subterranean habitats, acting as both predators and indicators of environmental health.
These remarkable cave dragons can grow up to 12 inches long and live for nearly 70 years, showcasing a unique biology that adapts them perfectly to life in darkness. As apex predators, olms primarily feed on small invertebrates, helping to regulate populations and maintain balance within their ecosystems.
Living in the biodiverse caves of Slovenia, olms contribute to an intricate web of life, comparable to tropical forests. Their low metabolism allows them to survive long periods without food, further emphasizing their adaptability in such nutrient-scarce environments.
Notably, juvenile olms experience a regression of their eyes during development, which become covered by a skin flap, enhancing their specialization for cave life.
Protecting these cave dragon habitats is essential, not just for the conservation of olms but for the overall health of karst ecosystems.
These ecosystems, critical sources of drinking water for millions, rely on olms as indicators of environmental changes, making their presence vital for maintaining biodiversity and ecological integrity in these unique subterranean worlds.
Threats to Cave DragonsCave dragons, particularly the olm, face numerous threats that jeopardize their fragile existence. These unique creatures rely on their sensitive ecosystems, which are increasingly vulnerable to various habitat threats. As you explore the intricate world of cave dragons, you'll discover the following dangers they encounter:
Pollution runoff contaminates their habitats, impacting water quality.Hydroelectric projects disrupt natural water supplies, altering karst landscapes.Environmental changes threaten their low metabolism, making survival difficult.Conservation efforts are essential to maintain biodiversity and ecosystem stability.Despite their ability to endure long periods without food, the olm's survival is in jeopardy as their habitats continue to degrade.
Conservation initiatives not only aim to protect cave dragons but also help guarantee that surrounding water systems remain healthy. Recent advancements in environmental DNA (eDNA) techniques provide valuable insights into olm populations, enhancing our understanding of their ecology and distribution amidst these growing habitat threats.
Exploration Challenges and Risks
Venturing into extensive cave systems presents a host of exploration challenges and risks that can easily overwhelm even seasoned spelunkers. The labyrinthine structures can disorient you, making navigation a real-life test of skill. You might find yourself traversing long distances in dimly lit passages, where every turn feels like stepping into an aura of mystery.
Even though you're equipped with the right gear, hazards like sharp stalactites and sudden rockfalls can pose serious threats.
Moreover, cave diving introduces additional risks, such as potential flooding and low oxygen levels. You'll need specialized training to handle these dangers safely. Limited access to certain areas of caves hinders your efforts to gather valuable information about hidden ecosystems. Who knows what kind of animal or even new species could be lurking in unexplored habitats?
Collaboration with researchers and conservationists becomes essential in mitigating these risks while you search for evidence of mythical creatures—something the first man who entered these caves could only dream of.
The quest for knowledge in these dark domains demands courage, preparation, and a keen awareness of the ever-present dangers.
Impact of Climate on Subterranean Life
Climate change casts a long shadow over the unique ecosystems found within subterranean environments. Over the years, shifts in climate patterns have directly impacted these delicate habitats, leading to potential declines or extinctions of species that rely on stable conditions.
Changes in water levels disrupt habitats, causing population declines.Temperature fluctuations can alter the metabolism and reproductive cycles of organisms, like the olm.Increased rainfall leads to contamination of cave waters, threatening clean ecosystems.Prolonged droughts can fragment habitats, reducing connectivity between cave systems.These factors create an unstable environment for cave-dwelling organisms. As nutrient cycles become disrupted, food availability dwindles, impacting community dynamics.
You might notice that the delicate balance sustaining these species is increasingly threatened. With climate change influencing external conditions, subterranean life, often hidden from our eyes, faces challenges that could reshape these ecosystems forever.
The consequences of climate change aren't just a future concern; they're happening now, and if we're not careful, we may lose the mysterious creatures that might be lurking in the shadows of our caves for years to come.
Scientific Discoveries and Findings
You're standing at the entrance of unexplored cave systems, where hidden ecosystems might hold the key to undiscovered species.
Fossil evidence of giants, like the woolly mammoth, hints at ancient life that roamed these dark passages.
As you explore further, you can't help but wonder what other mysteries lie beneath the surface.
Unexplored Cave EcosystemsMany researchers are uncovering the hidden wonders of unexplored cave ecosystems, revealing biodiversity that rivals that of tropical forests. These intricate networks, which have evolved over millions of years ago, are home to unique species like the olm, or cave dragon.
Recent advances in environmental DNA (eDNA) techniques allow you to identify elusive organisms without extensive physical exploration.
Here are some fascinating aspects of these ecosystems:
Many parts remain largely uncharted, holding the potential for new discoveries.Ongoing research continues to reveal new species and genetic variations.The delicate balance of life in these habitats is essential for ecological health.Preservation efforts are vital, as caves are vulnerable to pollution and disruption.As you explore the depths of these caves, you'll find that they hold secrets about past biodiversity and evolutionary processes.
Each exploration not only enhances our understanding but also emphasizes the importance of protecting these hidden worlds. The more you uncover, the clearer it becomes that the mysteries of cave ecosystems may offer insights into life on Earth that we've only just begun to grasp.
Fossil Evidence of GiantsExploring the fossil evidence of giants reveals an enchanting glimpse into Earth's prehistoric past. As you investigate the findings, you might be fascinated by the Irish elk, which stood around 7 feet tall and weighed over 1,000 pounds. This magnificent creature roamed the earth until about 11,000 years ago, likely succumbing to climate change and human hunting.
You may also stumble upon woolly mammoth skeletons, remnants of Ice Age mammals that traveled in herds, showcasing adaptations like thick fur and a layer of fat for insulation.
In North America, the giant ground sloth, discovered during tunnel construction in Los Angeles, reached lengths of up to 10 feet, illustrating the diversity of large herbivores during the Pleistocene epoch.
You can't ignore the remains of the thylacine, or Tasmanian tiger, found across Australia, shedding light on its behaviors before it became extinct due to overhunting and habitat loss.
Future Expeditions and Potential Unveiling
The future of cave exploration holds the promise of extraordinary discoveries, as expeditions investigate extensive underground systems that might reveal new species or subspecies with monster-like traits.
These explorations could reshape our understanding of biodiversity in isolated environments, especially in places like the Dinaric Alps, where reports of cave dragons have sparked intrigue.
Future expeditions may focus on:
Advanced techniques like eDNA analysis to uncover unknown organisms.Historical accounts that can inspire scientific verification of cryptids.Collaborative efforts among archaeologists, biologists, and speleologists.Unique adaptations observed in extreme cave conditions.Dating back to ancient folklore, these legends of monstrous beings can guide researchers in their quest.
As cave systems remain largely uncharted, the potential for finding creatures that defy conventional classification is immense.
By combining modern science with historical narratives, you could uncover evidence that challenges accepted notions of life on Earth.
Each expedition may unearth not only new species but also the stories behind them, forever altering our perspective on what lurks beneath the surface.
The thrill of discovery awaits, and you might just find something extraordinary.
ConclusionAs you venture into the depths of our planet, you can't help but wonder what secrets lie in the shadows of those ancient cave systems. The allure of hidden worlds beckons, and the whispers of legends remind you that monsters might not just be figments of imagination. Each exploration could reveal life forms that challenge your understanding of nature. So, keep your curiosity alive—who knows what wonders or terrors await in the dark, ready to rewrite the story of our world?
January 7, 2025
What if Monster Activity Interferes With Electronic Devices
If monster activity interferes with your electronic devices, expect chaos. You might notice flickering lights or devices turning off unexpectedly. This often happens due to emotional surges that impact energy levels around you. Your feelings can affect how your electronics behave, revealing patterns tied to your moods. For example, excitement or frustration may trigger device malfunctions. To manage these disruptions, try techniques like deep breathing or visualization to stabilize your energy. By recognizing the links between your emotions and device behavior, you can create a more harmonious environment. Stay tuned for insights on maneuvering through these peculiar experiences.
Key TakeawaysMonster activity can cause energy surges, leading to flickering lights and malfunctioning electronics, disrupting daily tasks.Emotional states, such as anger or excitement, may trigger specific electronic disturbances, indicating a connection between feelings and device behavior.Individuals sensitive to energy fluctuations might experience heightened disruptions, making self-awareness crucial for managing emotions and technology interactions.Techniques like deep breathing and visualization can help release pent-up energy, reducing the impact of monster activity on electronic devices.Understanding the relationship between emotional energy and electronics can provide insights into supernatural phenomena and enhance personal energy management.Effects of Monster Activity
Monster activity can release surprising energy surges that affect your electronic devices. You might notice odd behaviors, like your Google Slides presentation flickering or your lights dimming unexpectedly. These disturbances aren't just random glitches; they often signal emotional surges similar to those experienced by humans. When a surge occurs, devices can turn off or on spontaneously, leaving you frustrated mid-presentation.
If you're in an area known for paranormal activity, these effects can become even more pronounced. You may find that your devices behave erratically during moments of heightened emotional or spiritual occurrences. If you're sensitive to energy fluctuations, you might feel these disruptions acutely, as they can disrupt your focus and workflow.
Understanding the effects of monster activity on your electronics can help you become more aware of your surroundings. You might consider employing energy management techniques—like grounding yourself or creating a calming environment—to mitigate these disruptions.
Understanding Electronic Interference
Many people have experienced the frustrating phenomenon of electronic interference, often without understanding its root causes. This interference can manifest in various ways, such as flickering street lights or malfunctioning devices. These disruptions often coincide with heightened emotional states or energy fluctuations in your environment.
By grasping the connection between emotional energy and electronics, you can gain valuable insights into your experiences. Here's a simple table to illustrate some common manifestations of electronic interference:
ManifestationPossible TriggerEmotional StateFlickering street lightsSudden energy surgeAnger, anxietyDevices malfunctioningRelease of pent-up energyExcitement, frustrationElectronic devices resetHeightened emotional sensitivityFear, sadnessBeing aware of your emotional state can help you identify specific triggers for these disturbances. When you manage your energy effectively, you might find that electronic devices behave more reliably. Understanding this relationship sheds light on both personal experiences and broader phenomena, including those related to paranormal activities.
Emotional Triggers and Electronics
Often, people don't realize how their emotional triggers can directly affect the behavior of electronic devices around them. When you experience stress or heightened excitement, your energy levels can surge, causing nearby electronics to malfunction or act erratically. You might notice streetlights flickering or turning on and off, which often correlates with the emotional atmosphere in the area.
If you're sensitive to energy fluctuations, you may see patterns between your moods and the behavior of electronic devices. This connection can offer valuable insights into your personal energy management. By recognizing how your emotional states influence these malfunctions, you can become more self-aware.
For instance, if you find that your frustration leads to frequent electronic disruptions, you could adopt proactive strategies like deep breathing or visualization techniques to release that energy.
Awareness of your emotional triggers not only helps you understand your energy release patterns but also may reduce electronic interference in your environment. By managing your emotions, you can create a more harmonious relationship with the technology around you, minimizing unexpected disruptions and enhancing your daily experiences.
Techniques for Energy Management
Effective energy management techniques can significantly enhance your ability to maintain a balanced emotional state and reduce the impact on electronic devices. By mastering these techniques, you can create a harmonious environment for both yourself and your gadgets.
Here are four effective strategies to contemplate:
Deep Breathing: Practice deep breathing exercises to release pent-up energy. This helps mitigate stress and keeps your personal energy balanced, reducing interference with your devices.Visualization: Engage in visualization exercises where you imagine stress and negative energy leaving your body. This enhances relaxation and stabilizes energy fluctuations that could affect electronics.Self-Assessment: Regularly assess your emotional state. Recognizing stress triggers can prevent unexpected energy spikes that disrupt your devices' performance.Pattern Observation: Keep an eye on patterns in electronic malfunctions. Understanding how these patterns relate to your emotional states can provide insights to manage your energy more effectively.Exploring the Supernatural Connection
In the domain of the supernatural, the interaction between emotional energy and electronic devices raises intriguing questions. You might've noticed that when you're feeling intense emotions, your electronics sometimes misbehave. This isn't just coincidence; reports suggest that supernatural entities, or "monsters," can manipulate energy fields in ways that disrupt electronic devices.
When emotional states peak—whether from you or a lurking presence—you may experience odd device behavior, like unexpected shutdowns or sudden surges in power. Anecdotal evidence often ties ghost sightings to simultaneous tech malfunctions, hinting at a possible correlation between supernatural occurrences and electronic disturbances.
Understanding this dynamic can be your key to deciphering the unexplained. If you're experiencing erratic device behavior during moments of high emotion or reported paranormal activity, consider the energy at play.
It could be that the emotional intensity is creating spikes in energy that interfere with your gadgets. By recognizing these connections, you can better navigate your experiences and perhaps find comfort in understanding the supernatural influences around you.
ConclusionTo summarize, it's fascinating to note that over 70% of people believe they've experienced some form of electronic interference linked to paranormal activity. Whether it's flickering lights or glitches in your devices, understanding the connection between monster activity and electronics can help you navigate these eerie experiences. By recognizing emotional triggers and employing energy management techniques, you can regain control and perhaps even embrace the supernatural in a more harmonious way. Keep your devices ready—you never know what's lurking nearby!



